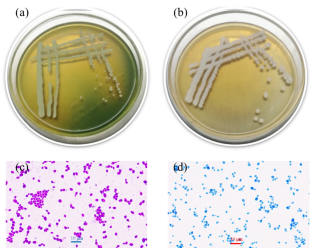
experiment of yeast fermentation

The fermentation of sugars using yeast: A discovery experiment
Charles Pepin (student) and Charles Marzzacco (retired), Melbourne, FL


Introduction
Enzyme catalysis 1 is an important topic which is often neglected in introductory chemistry courses. In this paper, we present a simple experiment involving the yeast-catalyzed fermentation of sugars. The experiment is easy to carry out, does not require expensive equipment and is suitable for introductory chemistry courses.
The sugars used in this study are sucrose and lactose (disaccharides), and glucose, fructose and galactose (monosaccharides). Lactose, glucose and fructose were obtained from a health food store and the galactose from Carolina Science Supply Company. The sucrose was obtained at the grocery store as white sugar. The question that we wanted to answer was “Do all sugars undergo yeast fermentation at the same rate?”
Sugar fermentation results in the production of ethanol and carbon dioxide. In the case of sucrose, the fermentation reaction is:
\[C_{12}H_{22}O_{11}(aq)+H_2 O\overset{Yeast\:Enzymes}{\longrightarrow}4C_{2}H_{5}OH(aq) + 4CO_{2}(g)\]
Lactose is also C 12 H 22 O 11 but the atoms are arranged differently. Before the disaccharides sucrose and lactose can undergo fermentation, they have to be broken down into monosaccharides by the hydrolysis reaction shown below:
\[C_{12}H_{22}O_{11} + H_{2}O \longrightarrow 2C_{6}H_{12}O_{6}\]
The hydrolysis of sucrose results in the formation of glucose and fructose, while lactose produces glucose and galactose.
sucrose + water \(\longrightarrow\) glucose + fructose
lactose + water \(\longrightarrow\) glucose + galactose
The enzymes sucrase and lactase are capable of catalyzing the hydrolysis of sucrose and lactose, respectively.
The monosaccharides glucose, fructose and galactose all have the molecular formula C 6 H 12 O 6 and ferment as follows:
\[C_{6}H_{12}O_{6}(aq)\overset{Yeast Enzymes}{\longrightarrow}2C_{2}H_{5}OH(aq) + 2CO_{2}(g)\]
In our experiments 20.0 g of the sugar was dissolved in 100 mL of tap water. Next 7.0 g of Red Star ® Quick-Rise Yeast was added to the solution and the mixture was microwaved for 15 seconds at full power in order to fully activate the yeast. (The microwave power is 1.65 kW.) This resulted in a temperature of about 110 o F (43 o C) which is in the recommended temperature range for activation. The cap was loosened to allow the carbon dioxide to escape. The mass of the reaction mixture was measured as a function of time. The reaction mixture was kept at ambient temperature, and no attempt at temperature control was used. Each package of Red Star Quick-Rise Yeast has a mass of 7.0 g so this amount was selected for convenience. Other brands of baker’s yeast could have been used.
This method of studying chemical reactions has been reported by Lugemwa and Duffy et al. 2,3 We used a balance good to 0.1 g to do the measurements. Although fermentation is an anaerobic process, it is not necessary to exclude oxygen to do these experiments. Lactose and galactose dissolve slowly. Mild heat using a microwave greatly speeds up the process. When using these sugars, allow the sugar solutions to cool to room temperature before adding the yeast and microwaving for an additional 15 seconds.
Fermentation rate of sucrose, lactose alone, and lactose with lactase
Fig. 1 shows plots of mass loss vs time for sucrose, lactose alone and lactose with a dietary supplement lactase tablet added 1.5 hours before starting the experiment. All samples had 20.0 g of the respective sugar and 7.0 g of Red Star Quick-Rise Yeast. Initially the mass loss was recorded every 30 minutes. We continued taking readings until the mass leveled off which was about 600 minutes. If one wanted to speed up the reaction, a larger amount of yeast could be used. The results show that while sucrose readily undergoes mass loss and thus fermentation, lactose does not. Clearly the enzymes in the yeast are unable to cause the lactose to ferment. However, when lactase is present significant fermentation occurs. Lactase causes lactose to split into glucose and galactose. A comparison of the sucrose fermentation curve with the lactose containing lactase curve shows that initially they both ferment at the same rate.

Fig. 1. Comparison of the mass of CO 2 released vs time for the fermentation of sucrose, lactose alone, and lactose with a lactase tablet. Each 20.0 g sample was dissolved in 100 mL of tap water and then 7.0 g of Red Star Quick-Rise Yeast was added.
However, when the reactions go to completion, the lactose, lactase and yeast mixture gives off only about half as much CO 2 as the sucrose and yeast mixture. This suggests that one of the two sugars that result when lactose undergoes hydrolysis does not undergo yeast fermentation. In order to verify this, we compared the rates of fermentation of glucose and galactose using yeast and found that in the presence of yeast glucose readily undergoes fermentation while no fermentation occurs in galactose.

Fig. 2. Comparison of the mass of CO 2 released vs time for the fermentation of sucrose, glucose and fructose. Each 20 g sugar sample was dissolved in 100 mL of water and then 7.0 g of yeast was added.
Fermentation rate of sucrose, glucose and fructose
Next we decided to compare the rate of fermentation of sucrose with that glucose and fructose, the two compounds that make up sucrose. We hypothesized that the disaccharide would ferment more slowly because it would first have to undergo hydrolysis. In fact, though, Fig. 2 shows that the three sugars give off CO 2 at about the same rate. Our hypothesis was wrong. Although there is some divergence of the three curves at longer times, the sucrose curve is always as high as or higher than the glucose and fructose curves. The observation that the total amount of CO 2 released at the end is not the same for the three sugars may be due to the purity of the fructose and glucose samples not being as high as that of the sucrose.
Fermentation rate and sugar concentration
Next, we decided to investigate how the rate of fermentation depends on the concentration of the sugar. Fig. 3 shows the yeast fermentation curves for 10.0 g and 20.0 g of glucose. It can be seen that the initial rate of CO 2 mass loss is the same for the 10.0 and 20.0 g samples. Of course the total amount of CO 2 given off by the 20.0 g sample is twice as much as that for the 10.0 g sample as is expected. Later, we repeated this experiment using sucrose in place of glucose and obtained the same result.

Fig. 3. Comparison of the mass of CO 2 released vs time for the fermentation of 20.0 g of glucose and 10.0 g of glucose. Each sugar sample was dissolved in 100 mL of water and then 7.0 g of yeast was added.
Fermentation rate and yeast concentration
After seeing that the rate of yeast fermentation does not depend on the concentration of sugar under the conditions of our experiments, we decided to see if it depends on the concentration of the yeast. We took two 20.0 g samples of glucose and added 7.0 g of yeast to one and 3.5 g to the other. The results are shown in Fig. 4. It can clearly be seen that the rate of CO 2 release does depend on the concentration of the yeast. The slope of the sample with 7.0 g of yeast is about twice as large as that with 3.5 g of yeast. We repeated the experiment with sucrose and fructose in place of glucose and obtained similar results.

Fig. 4. Comparison of the mass of CO 2 released vs time for the fermentation of two 20.0 g samples of glucose dissolved in 100 mL of water. One had 7.0 g of yeast and the other had 3.5 g of yeast.
In hindsight, the observation that the rate of fermentation is dependent on the concentration of yeast but independent of the concentration of sugar is not surprising. Enzyme saturation can be explained to students in very simple terms. A molecule such as glucose is rather small compared to a typical enzyme. Enzymes are proteins with large molar masses that are typically greater than 100,000 g/mol. 1 Clearly, there are many more glucose molecules in the reaction mixture than enzyme molecules. The large molecular ratio of sugar to enzyme clearly means that every enzyme site is occupied by a sugar molecule. Thus, doubling or halving the sugar concentration cannot make a significant difference in the initial rate of the reaction. On the other hand, doubling the concentration of the enzyme should double the rate of reaction since you are doubling the number of enzyme sites.
The experiments described here are easy to perform and require only a balance good to 0.1 g and a timer. The results of these experiments can be discussed at various levels of sophistication and are consistent with enzyme kinetics as described by the Michaelis-Menten model. 1 The experiments can be extended to look at the effect of temperature on the rate of reaction. For enzyme reactions such as this, the reaction does not take place if the temperature is too high because the enzymes get denatured. The effect of pH and salt concentration can also be investigated.
- Jeremy M. Berg, John L. Tymoczko and Lubert Stryer, Biochemistry , 6th edition, W.H. Freeman and Company, 2007, pages 205-237.
- Fugentius Lugemwa, Decomposition of Hydrogen Peroxide, Chemical Educator , April 2013, pages 85-87.
- Daniel Q. Duffy, Stephanie A. Shaw, William D. Bare, Kenneth A. Goldsby, More Chemistry in a Soda Bottle, A Conservation of Mass Activity, Journal of Chemical Education , August 1995, pages 734-736.
- Jessica L Epstein, Matthew Vieira, Binod Aryal, Nicolas Vera and Melissa Solis, Developing Biofuel in the Teaching Laboratory: Ethanol from Various Sources, Journal of Chemical Education , April 2010, pages 708–710.
More about April 2015

Department of Chemistry 200 University Ave. W Waterloo, Ontario, Canada N2L 3G1
Get Your ALL ACCESS Shop Pass here →

Yeast Fermentation Experiment
Fermentation is a fascinating process that kids can easily explore through a simple experiment using yeast and sugar. This hands-on activity teaches students about fermentation and introduces them to the scientific method, data collection, and analysis.

Investigate how different types of sugar (white, brown, and honey) affect the rate of yeast fermentation by measuring the amount of carbon dioxide (CO₂) produced.
Example Hypothesis: If yeast is added to different types of sugar, then the type of sugar will affect the amount of carbon dioxide produced, with white sugar producing more CO₂ than the others.
💡 Learn more about using the scientific method [here] and choosing variables .
Watch the Video:
- Active dry yeast
- White sugar
- Brown sugar
- Measuring spoons and measuring cups
- Small bottles or test tubes
- Rubber bands
- Ruler or measuring tape
- Notebook and pen for recording data ( grab free journal sheets here )
- Printable Experiment Page (see below)

Instructions:
STEP 1. Prepare a yeast solution by dissolving a packet of active dry yeast in warm water according to the package instructions.
STEP 2. Label 3 bottles and add 1 tablespoon of white sugar to the “White Sugar” bottle. Add 1 tablespoon of brown sugar to the “Brown Sugar” bottle. Measure 1 tablespoon of honey and add it to the “Honey” bottle.
STEP 3. Measure and pour an equal amount of the yeast solution into each bottle, ensuring the yeast is well mixed with the sugar.
STEP 4. Quickly stretch a balloon over the mouth of each bottle. Secure the balloons with rubber bands if needed. Ensure the balloons are sealed tightly to prevent CO₂ from escaping.
STEP 5. Place the bottles in a warm, consistent environment to promote fermentation.
STEP 6. Observe and record the size of the balloons at regular intervals (e.g., every 15 minutes) for 1-2 hours. Use a ruler or measuring tape to measure the circumference of each balloon.
TIP: Note the time it takes for the balloons to start inflating and the differences in balloon size over time for each type of sugar.
STEP 7: Analyze the data by comparing the amount of CO₂ produced (balloon size) for each type of sugar. Create a graph showing the balloon size over time for each sugar type.
STEP 8. Determine which sugar type resulted in the most and least CO₂ production. Discuss possible reasons for the differences, considering what each sugar is made of. Think about whether the results support or disprove the hypothesis. Can you come up with further experiments or variations to explore other factors affecting yeast fermentation?

Free Printable Yeast and Sugar Experiment Project
Grab the free fermentation experiment worksheet here. Join our STEM club for a printable version of the video!

The Science Behind Yeast Fermentation
For Our Younger Scientists: Yeast is a type of fungus that feeds on sugars. When you mix yeast with sugar and water, it starts to eat the sugar and convert it into alcohol and carbon dioxide gas. The gas gets trapped in the balloon, causing it to inflate. This shows that fermentation is happening!
Yeast fermentation is a biological process where yeast converts sugars into alcohol and carbon dioxide (CO₂) in the absence of oxygen. This process is used in baking, brewing, wine making and biofuel production. How much fermentation occurs can vary depending on the type of sugar used.
Yeast contains enzymes that break down sugar molecules through a series of chemical reactions . Here’s how it works:
Enzymes are molecules, usually proteins, that act as catalysts to speed up chemical reactions within living organisms.
First the yeast is mixed with warm water, and it becomes activated. The warm environment “wakes up” the yeast cells, preparing them to consume sugars.
Yeast cells produce enzymes that break down sugar molecules (sucrose, glucose, and fructose) into simpler molecules. This process is called glycolysis. During glycolysis, sugar molecules are converted into pyruvate, releasing a small amount of energy.
In the absence of oxygen (anaerobic conditions), yeast cells convert pyruvate into ethanol (alcohol) and carbon dioxide gas (CO₂). The carbon dioxide produced during fermentation is what inflates the balloons in the experiment.
Different Sugars & Fermentation
Different sugars can affect the rate of fermentation. This is how:
- White Sugar (Sucrose): Composed of glucose and fructose and is easily broken down by yeast, leading to efficient CO₂ production.
- Brown Sugar: Contains sucrose along with molasses, which includes minerals and additional nutrients. May result in a slightly different fermentation rate due to its composition.
- Honey: Contains a mixture of glucose, fructose, and other components. The additional components can influence the fermentation process, potentially leading to different CO₂ production rates compared to pure sucrose.
The amount of CO₂ produced depends on how easily the yeast can break down the sugar molecules and convert them into ethanol and CO₂. Sugars that are more readily broken down by yeast will typically produce more CO₂ faster.
More Fun Science Experiments
Explore chemistry , biology and more, including…
- Bread Mold Experiment
- Baking Soda Balloon Experiment
- Bread In A Bag
- Elephant Toothpaste
- Mentos and Soda

Helpful Science Resources To Get You Started
Here are a few resources that will help you introduce science more effectively to your kiddos or students and feel confident presenting materials. You’ll find helpful free printables throughout.
- Best Science Practices (as it relates to the scientific method)
- Science Vocabulary
- All About Scientists
- Free Science Worksheets
- DIY Science Kits
- Science Tools for Kids
- Scientific Method for Kids
- Citizen Science Guide
- Join us in the Club
Printable Science Projects For Kids
If you’re looking to grab all of our printable science projects in one convenient place plus exclusive worksheets and bonuses like a STEAM Project pack, our Science Project Pack is what you need! Over 300+ Pages!
- 90+ classic science activities with journal pages, supply lists, set up and process, and science information. NEW! Activity-specific observation pages!
- Best science practices posters and our original science method process folders for extra alternatives!
- Be a Collector activities pack introduces kids to the world of making collections through the eyes of a scientist. What will they collect first?
- Know the Words Science vocabulary pack includes flashcards, crosswords, and word searches that illuminate keywords in the experiments!
- My science journal writing prompts explore what it means to be a scientist!!
- Bonus STEAM Project Pack: Art meets science with doable projects!
- Bonus Quick Grab Packs for Biology, Earth Science, Chemistry, and Physics

Subscribe to receive a free 5-Day STEM Challenge Guide
~ projects to try now ~.

Choose an Account to Log In

Notifications
Science project, growing yeast: sugar fermentation.

Yeast is most commonly used in the kitchen to make dough rise. Have you ever watched pizza crust or a loaf of bread swell in the oven? Yeast makes the dough expand. But what is yeast exactly and how does it work? Yeast strains are actually made up of living eukaryotic microbes, meaning that they contain cells with nuclei. Being classified as fungi (the same kingdom as mushrooms), yeast is more closely related to you than plants! In this experiment we will be watching yeast come to life as it breaks down sugar, also known as sucrose , through a process called fermentation . Let’s explore how this happens and why!
What is sugar’s effect on yeast?
- 3 Clear glass cups
- 2 Teaspoons sugar
- Water (warm and cold)
- 3 Small dishes
- Permanent marker

- Fill all three dishes with about 2 inches of cold water
- Place your clear glasses in each dish and label them 1, 2, and 3.
- In glass 1, mix one teaspoon of yeast, ¼ cup of warm water, and 2 teaspoons of sugar.
- In glass 2, mix one teaspoon of yeast with ¼ cup of warm water.
- In glass 3, place one teaspoon of yeast in the glass.
- Observe each cups reaction. Why do you think the reactions in each glass differed from one another? Try using more of your senses to evaluate your three glasses; sight, touch, hearing and smell especially!
The warm water and sugar in glass 1 caused foaming due to fermentation.
Fermentation is a chemical process of breaking down a particular substance by bacteria, microorganisms, or in this case, yeast. The yeast in glass 1 was activated by adding warm water and sugar. The foaming results from the yeast eating the sucrose. Did glass 1 smell different? Typically, the sugar fermentation process gives off heat and/or gas as a waste product. In this experiment glass 1 gave off carbon dioxide as its waste.
Yeast microbes react different in varying environments. Had you tried to mix yeast with sugar and cold water, you would not have had the same results. The environment matters, and if the water were too hot, it would kill the yeast microorganisms. The yeast alone does not react until sugar and warm water are added and mixed to create the fermentation process. To further investigate how carbon dioxide works in this process, you can mix yeast, warm water and sugar in a bottle while attaching a balloon to the open mouth. The balloon will expand as the gas from the yeast fermentation rises.
Related learning resources
Add to collection, create new collection, new collection, new collection>, sign up to start collecting.
Bookmark this to easily find it later. Then send your curated collection to your children, or put together your own custom lesson plan.
Remember Me

Shop Experiment Sugar Fermentation Experiments
Sugar fermentation.
Experiment #12B from Biology with Vernier

Introduction
Yeast are able to metabolize some foods, but not others. In order for an organism to make use of a potential source of food, it must be capable of transporting the food into its cells. It must also have the proper enzymes capable of breaking the food’s chemical bonds in a useful way. Sugars are vital to all living organisms. Yeast are capable of using some, but not all sugars as a food source. Yeast can metabolize sugar in two ways, aerobically, with the aid of oxygen, or anaerobically , without oxygen.
In this lab, you will try to determine whether yeast are capable of metabolizing a variety of sugars. Although the aerobic fermentation of sugars is much more efficient, in this experiment we will have yeast ferment the sugars anaerobically. When the yeast respire aerobically, oxygen gas is consumed at the same rate that CO 2 is produced—there would be no change in the gas pressure in the test tube. When yeast ferment the sugars anaerobically, however, CO 2 production will cause a change in the pressure of a closed test tube, since no oxygen is being consumed. We can use this pressure change to monitor the fermentation rate and metabolic activity of the organism.
The fermentation of glucose can be described by the following equation:
Note that alcohol is a byproduct of this fermentation.
In this experiment, you will
- Use a Gas Pressure Sensor to measure the pressure change caused by carbon dioxide released during fermentation.
- Determine the rate of fermentation.
- Determine which sugars yeast can metabolize.
Sensors and Equipment
This experiment features the following sensors and equipment. Additional equipment may be required.

Ready to Experiment?
Ask an expert.
Get answers to your questions about how to teach this experiment with our support team.
- Call toll-free: 888-837-6437
- Chat with Us
- Email [email protected]
Purchase the Lab Book
This experiment is #12B of Biology with Vernier . The experiment in the book includes student instructions as well as instructor information for set up, helpful hints, and sample graphs and data.

This page has been archived and is no longer updated
Yeast Fermentation and the Making of Beer and Wine
Once upon a time, many, many years ago, a man found a closed fruit jar containing a honeybee. When he drank the contents, he tasted a new, strange flavor. Suddenly his head was spinning, he laughed for no reason, and he felt powerful. He drank all the liquid in the jar. The next day he experienced an awful feeling. He had a headache, pain , an unpleasant taste in his mouth, and dizziness — he had just discovered the hangover. You might think this is just a tale, but is it? Several archaeological excavations have discovered jars containing the remains of wine that are 7,000 years old (McGovern, 2009), and it is very likely that humankind's first encounter with alcoholic beverages was by chance. How did this chance discovery lead to the development of the beer and wine industry (Figure 1), and how did scientists eventually learn about the biological mechanisms of alcohol production?
The History of Beer and Wine Production
Over the course of human history, and using a system of trial, error, and careful observation, different cultures began producing fermented beverages. Mead, or honey wine, was produced in Asia during the Vedic period (around 1700–1100 BC), and the Greeks, Celts, Saxons, and Vikings also produced this beverage. In Egypt, Babylon, Rome, and China, people produced wine from grapes and beer from malted barley. In South America, people produced chicha from grains or fruits, mainly maize; while in North America, people made octli (now known as "pulque") from agave, a type of cactus (Godoy et al. 2003).
At the time, people knew that leaving fruits and grains in covered containers for a long time produced wine and beer, but no one fully understood why the recipe worked. The process was named fermentation, from the Latin word fervere , which means "to boil." The name came from the observation that mixtures of crushed grapes kept in large vessels produced bubbles, as though they were boiling. Producing fermented beverages was tricky. If the mixture did not stand long enough, the product contained no alcohol; but if left for too long, the mixture rotted and was undrinkable. Through empirical observation, people learned that temperature and air exposure are key to the fermentation process.
Wine producers traditionally used their feet to soften and grind the grapes before leaving the mixture to stand in buckets. In so doing, they transferred microorganisms from their feet into the mixture. At the time, no one knew that the alcohol produced during fermentation was produced because of one of these microorganisms — a tiny, one-celled eukaryotic fungus that is invisible to the naked eye: yeast . It took several hundred years before quality lenses and microscopes revolutionized science and allowed researchers to observe these microorganisms.
Yeast and Fermentation
Figure 1: Fermented beverages such as wine have been produced by different human cultures for centuries. Christian Draghici/Shutterstock. All rights reserved. In the seventeenth century, a Dutch tradesman named Antoni van Leeuwenhoek developed high-quality lenses and was able to observe yeast for the first time. In his spare time Leeuwenhoek used his lenses to observe and record detailed drawings of everything he could, including very tiny objects, like protozoa, bacteria , and yeast. Leeuwenhoek discovered that yeast consist of globules floating in a fluid, but he thought they were merely the starchy particles of the grain from which the wort (liquid obtained from the brewing of whiskey and beer) was made (Huxley 1894). Later, in 1755, yeast were defined in the Dictionary of the English Language by Samuel Johnson as "the ferment put into drink to make it work; and into bread to lighten and swell it." At the time, nobody believed that yeast were alive; they were seen as just organic chemical agents required for fermentation.
In the eighteenth and nineteenth centuries, chemists worked hard to decipher the nature of alcoholic fermentation through analytical chemistry and chemical nomenclature. In 1789, the French chemist Antoine Lavoisier was working on basic theoretical questions about the transformations of substances. In his quest, he decided to use sugars for his experiments, and he gained new knowledge about their structures and chemical reactions. Using quantitative studies, he learned that sugars are composed of a mixture of hydrogen, charcoal (carbon), and oxygen.
Lavoisier was also interested in analyzing the mechanism by which sugarcane is transformed into alcohol and carbon dioxide during fermentation. He estimated the proportions of sugars and water at the beginning of the chemical reaction and compared them with the alcohol and carbon dioxide proportions obtained at the end. For the alcoholic reaction to proceed, he also added yeast paste (or "ferment," as it was called). He concluded that sugars were broken down through two chemical pathways: Two-thirds of the sugars were reduced to form alcohol, and the other third were oxidized to form carbon dioxide (the source of the bubbles observed during fermentation). Lavoisier predicted (according to his famous conservation-of-mass principle) that if it was possible to combine alcohol and carbon dioxide in the right proportions, the resulting product would be sugar. The experiment provided a clear insight into the basic chemical reactions needed to produce alcohol. However, there was one problem: Where did the yeast fit into the reaction? The chemists hypothesized that the yeast initiated alcoholic fermentation but did not take part in the reaction. They assumed that the yeast remained unchanged throughout the chemical reactions.
Yeast Are Microorganisms
In 1815 the French chemist Joseph-Louis Gay-Lussac made some interesting observations about yeast. Gay-Lussac was experimenting with a method developed by Nicolas Appert, a confectioner and cooker, for preventing perishable food from rotting. Gay-Lussac was interested in using the method to maintain grape juice wort in an unfermented state for an indefinite time. The method consisted of boiling the wort in a vessel, and then tightly closing the vessel containing the boiling fluid to avoid exposure to air. With this method, the grape juice remained unfermented for long periods as long as the vessel was kept closed. However, if yeast (ferment) was introduced into the wort after the liquid cooled, the wort would begin to ferment. There was now no doubt that yeast were indispensable for alcoholic fermentation. But what role did they play in the process?
When more powerful microscopes were developed, the nature of yeast came to be better understood. In 1835, Charles Cagniard de la Tour, a French inventor, observed that during alcoholic fermentation yeast multiply by gemmation (budding). His observation confirmed that yeast are one-celled organisms and suggested that they were closely related to the fermentation process. Around the same time, Theodor Schwann, Friedrich Kützing, and Christian Erxleben independently concluded that "the globular, or oval, corpuscles which float so thickly in the yeast [ferment] as to make it muddy" were living organisms (Barnett 1998). The recognition that yeast are living entities and not merely organic residues changed the prevailing idea that fermentation was only a chemical process. This discovery paved the way to understand the role of yeast in fermentation.
Pasteur Demonstrates the Role of Yeast in Fermentation
Pasteur performed careful experiments and demonstrated that the end products of alcoholic fermentation are more numerous and complex than those initially reported by Lavoisier. Along with alcohol and carbon dioxide, there were also significant amounts of glycerin, succinic acid, and amylic alcohol (some of these molecules were optical isomers — a characteristic of many important molecules required for life). These observations suggested that fermentation was an organic process. To confirm his hypothesis, Pasteur reproduced fermentation under experimental conditions, and his results showed that fermentation and yeast multiplication occur in parallel. He realized that fermentation is a consequence of the yeast multiplication, and the yeast have to be alive for alcohol to be produced. Pasteur published his seminal results in a preliminary paper in 1857 and in a final version in 1860, which was titled "Mémoire sur la fermentation alcoolique" (Pasteur 1857).
In 1856, a man named Bigo sought Pasteur's help because he was having problems at his distillery, which produced alcohol from sugar beetroot fermentation. The contents of his fermentation containers were embittered, and instead of alcohol he was obtaining a substance similar to sour milk. Pasteur analyzed the chemical contents of the sour substance and found that it contained a substantial amount of lactic acid instead of alcohol. When he compared the sediments from different containers under the microscope, he noticed that large amounts of yeast were visible in samples from the containers in which alcoholic fermentation had occurred. In contrast, in the polluted containers, the ones containing lactic acid, he observed "much smaller cells than the yeast." Pasteur's finding showed that there are two types of fermentation: alcoholic and lactic acid. Alcoholic fermentation occurs by the action of yeast; lactic acid fermentation, by the action of bacteria.
Isolating the Cell's Chemical Machinery
By the end of the nineteenth century, Eduard Buchner had shown that fermentation could occur in yeast extracts free of cells, making it possible to study fermentation biochemistry in vitro . He prepared cell-free extracts by carefully grinding yeast cells with a pestle and mortar. The resulting moist mixture was put through a press to obtain a "juice" to which sugar was added. Using a microscope, Buchner confirmed that there were no living yeast cells in the extract.
Upon studying the cell-free extracts, Buchner detected zymase, the active constituent of the extracts that carries out fermentation. He realized that the chemical reactions responsible for fermentation were occurring inside the yeast. Today researchers know that zymase is a collection of enzymes (proteins that promote chemical reactions). Enzymes are part of the cellular machinery, and all of the chemical reactions that occur inside cells are catalyzed and modulated by enzymes. For his discoveries, Buchner was awarded the Nobel Prize in Chemistry in 1907 (Barnett 2000; Barnett & Lichtenthaler 2001; Encyclopaedia Britannica 2010).
Around 1929, Karl Lohmann, Yellapragada Subbarao, and Cirus Friske independently discovered an essential molecule called adenosine triphosphate ( ATP ) in animal tissues. ATP is a versatile molecule used by enzymes and other proteins in many cellular processes. It is required for many chemical reactions, such as sugar degradation and fermentation (Voet & Voet 2004). In 1941, Fritz Albert Lipmann proposed that ATP was the main energy transfer molecule in the cell.
Sugar Decomposition
Glycolysis — the metabolic pathway that converts glucose (a type of sugar) into pyruvate — is the first major step of fermentation or respiration in cells. It is an ancient metabolic pathway that probably developed about 3.5 billion years ago, when no oxygen was available in the environment . Glycolysis occurs not only in microorganisms, but in every living cell (Nelson & Cox 2008).
Because of its importance, glycolysis was the first metabolic pathway resolved by biochemists. The scientists studying glycolysis faced an enormous challenge as they figured out how many chemical reactions were involved, and the order in which these reactions took place. In glycolysis, a single molecule of glucose (with six carbon atoms) is transformed into two molecules of pyruvic acid (each with three carbon atoms).
In order to understand glycolysis, scientists began by analyzing and purifying the labile component of cell-free extracts, which Buchner called zymase. They also detected a low-molecular-weight, heat-stable molecule, later called cozymase. Using chemical analyses, they learned that zymase is a complex of several enzymes; and cozymase is a mixture of ATP, ADP (adenosine diphosphate, a hydrolyzed form of ATP), metals, and coenzymes (substances that combine with proteins to make them functional), such as NAD + (nicotinamide adenine dinucleotide). Both components were required for fermentation to occur.
The complete glycolytic pathway, which involves a sequence of ten chemical reactions, was elucidated around 1940. In glycolysis, two molecules of ATP are produced for each broken molecule of glucose. During glycolysis, two reduction-oxidation (redox) reactions occur. In a redox reaction, one molecule is oxidized by losing electrons, while the other molecule is reduced by gaining those electrons. A molecule called NADH acts as the electron carrier in glycolysis, and this molecule must be reconstituted to ensure continuity of the glycolysis pathway.
The Chemical Process of Fermentation
In the absence of oxygen (anoxygenic conditions), pyruvic acid can follow two different routes, depending on the type of cell . It can be converted into ethanol (alcohol) and carbon dioxide through the alcoholic fermentation pathway, or it can be converted into lactate through the lactic acid fermentation pathway (Figure 3).
Since Pasteur's work, several types of microorganisms (including yeast and some bacteria) have been used to break down pyruvic acid to produce ethanol in beer brewing and wine making. The other by-product of fermentation, carbon dioxide, is used in bread making and the production of carbonated beverages. Other living organisms (such as humans) metabolize pyruvic acid into lactate because they lack the enzymes needed for alcohol production, and in mammals lactate is recycled into glucose by the liver (Voet & Voet 2004).
Selecting Yeast in Beer Brewing and Wine Making
Humankind has benefited from fermentation products, but from the yeast's point of view, alcohol and carbon dioxide are just waste products. As yeast continues to grow and metabolize sugar, the accumulation of alcohol becomes toxic and eventually kills the cells (Gray 1941). Most yeast strains can tolerate an alcohol concentration of 10–15% before being killed. This is why the percentage of alcohol in wines and beers is typically in this concentration range. However, like humans, different strains of yeast can tolerate different amounts of alcohol. Therefore, brewers and wine makers can select different strains of yeast to produce different alcohol contents in their fermented beverages, which range from 5 percent to 21 percent of alcohol by volume. For beverages with higher concentrations of alcohol (like liquors), the fermented products must be distilled.
Today, beer brewing and wine making are huge, enormously profitable agricultural industries. These industries developed from ancient and empirical knowledge from many different cultures around the world. Today this ancient knowledge has been combined with basic scientific knowledge and applied toward modern production processes. These industries are the result of the laborious work of hundreds of scientists who were curious about how things work.
References and Recommended Reading
Barnett, J. A. A history of research on yeast 1: Work by chemists and biologists, 1789–1850. Yeast 14 , 1439–1451 (1998)
Barnett, J. A. A history of research on yeast 2: Louis Pasteur and his contemporaries, 1850–1880. Yeast 16 , 755–771 (2000)
Barnett, J. A. & Lichtenthaler, F. W. A history of research on yeast 3: Emil Fischer, Eduard Buchner and their contemporaries, 1880–1900. Yeast 18 , 363–388 (2001)
Encyclopaedia Britannica's Guide to the Nobel Prizes (2010)
Godoy, A., Herrera, T. & Ulloa, M. Más allá del pulque y el tepache: Las bebidas alcohólicas no destiladas indígenas de México. Mexico: UNAM, Instituto de Investigaciones Antropológicas, 2003
Gray, W. D. Studies on the alcohol tolerance of yeasts . Journal of Bacteriology 42 , 561–574 (1941)
Huxley, T. H. Popular Lectures and Addresses II . Chapter IV, Yeast (1871). Macmillan, 1894
Jacobs, J. Ethanol from sugar: What are the prospects for US sugar crops? Rural Cooperatives 73 (5) (2006)
McGovern, P. E. Uncorking the Past: The Quest for Wine, Beer, and Other Alcoholic Beverages. Berkeley: University of California Press, 2009
Nelson, D. L. & Cox, M. M. Lehninger Principles of Biochemistry , 5th ed. New York: Freeman, 2008
Pasteur, L. Mémoire sur la fermentation alcoolique .Comptes Rendus Séances de l'Academie des Sciences 45 , 913–916, 1032–1036 (1857)
Pasteur, L. Studies on Fermentation . London: Macmillan, 1876
Voet, D. & Voet, J. Biochemistry. Vol. 1, Biomolecules, Mechanisms of Enzyme Action, and Metabolism , 3rd ed. New York: Wiley, 2004
Classic papers:
Meyerhof, O. & Junowicz-Kocholaty, R. The equilibria of isomerase and aldolase, and the problem of the phosphorylation of glyceraldehyde phosphate . Journal of Biological Chemistry 149 , 71–92 (1943)
Meyerhof, O. The origin of the reaction of harden and young in cell-free alcoholic fermentation . Journal of Biological Chemistry 157 , 105–120 (1945)
Meyerhof, O. & Oesper, P. The mechanism of the oxidative reaction in fermentation . Journal of Biological Chemistry 170 , 1–22 (1947)
Pasteur, L. Mèmoire sur la fermentation appeleé lactique . Annales de Chimie et de Physique 3e. sér. 52 , 404–418 (1858)
- Add Content to Group
Article History
Flag inappropriate.


Email your Friend

- | Lead Editor: Gary Coté , Mario De Tullio

Within this Subject (27)
- Basic (5)
- Intermediate (22)
Other Topic Rooms
- Gene Inheritance and Transmission
- Gene Expression and Regulation
- Nucleic Acid Structure and Function
- Chromosomes and Cytogenetics
- Evolutionary Genetics
- Population and Quantitative Genetics
- Genes and Disease
- Genetics and Society
- Cell Origins and Metabolism
- Proteins and Gene Expression
- Subcellular Compartments
- Cell Communication
- Cell Cycle and Cell Division
© 2014 Nature Education
- Press Room |
- Terms of Use |
- Privacy Notice |

Visual Browse
Your browser is not supported
Sorry but it looks as if your browser is out of date. To get the best experience using our site we recommend that you upgrade or switch browsers.
Find a solution
- Skip to main content
- Skip to navigation

- Back to parent navigation item
- Primary teacher
- Secondary/FE teacher
- Early career or student teacher
- Higher education
- Curriculum support
- Literacy in science teaching
- Periodic table
- Interactive periodic table
- Climate change and sustainability
- Resources shop
- Collections
- Remote teaching support
- Starters for ten
- Screen experiments
- Assessment for learning
- Microscale chemistry
- Faces of chemistry
- Classic chemistry experiments
- Nuffield practical collection
- Anecdotes for chemistry teachers
- On this day in chemistry
- Global experiments
- PhET interactive simulations
- Chemistry vignettes
- Context and problem based learning
- Journal of the month
- Chemistry and art
- Art analysis
- Pigments and colours
- Ancient art: today's technology
- Psychology and art theory
- Art and archaeology
- Artists as chemists
- The physics of restoration and conservation
- Ancient Egyptian art
- Ancient Greek art
- Ancient Roman art
- Classic chemistry demonstrations
- In search of solutions
- In search of more solutions
- Creative problem-solving in chemistry
- Solar spark
- Chemistry for non-specialists
- Health and safety in higher education
- Analytical chemistry introductions
- Exhibition chemistry
- Introductory maths for higher education
- Commercial skills for chemists
- Kitchen chemistry
- Journals how to guides
- Chemistry in health
- Chemistry in sport
- Chemistry in your cupboard
- Chocolate chemistry
- Adnoddau addysgu cemeg Cymraeg
- The chemistry of fireworks
- Festive chemistry
- Education in Chemistry
- Teach Chemistry
- On-demand online
- Live online
- Selected PD articles
- PD for primary teachers
- PD for secondary teachers
- What we offer
- Chartered Science Teacher (CSciTeach)
- Teacher mentoring
- UK Chemistry Olympiad
- Who can enter?
- How does it work?
- Resources and past papers
- Top of the Bench
- Schools' Analyst
- Regional support
- Education coordinators
- RSC Yusuf Hamied Inspirational Science Programme
- RSC Education News
- Supporting teacher training
- Interest groups

- More navigation items
Yeast and the expansion of bread dough
In association with Nuffield Foundation
- No comments
Try this class practical to investigate how temperature affects yeast and the expansion of bread dough
Yeast is a microbe used in bread making which feeds on sugar. Enzymes in yeast ferment sugar forming carbon dioxide and ethanol. The carbon dioxide makes the bread rise, while the ethanol evaporates when the bread is baked. In this experiment, students investigate the effect of different temperatures on yeast activity and the expansion of the bread dough.
It is best if each group does the activity at one temperature and then shares the results with other groups.
- Spatula or glass rod
- Beaker, 100 cm 3
- Measuring cylinder, 250 cm 3
- Measuring cylinder, 50 cm 3
- Thermometer, 0–100 °C
- Graph paper
- Access to a balance (1 d.p.)
- Access to water baths set at 20 °C, 30 °C and 37 °C (see note 2 below)
- Plain flour, 25 g
- Yeast suspension, 30 cm 3 (see note 3 below)
Health, safety and technical notes
- Read our standard health and safety guidance.
- If thermostatically controlled water baths are not available then large beakers of water maintained at the three temperatures can be used. The water temperature in each beaker needs to be monitored using a thermometer, and access to a supply of hot water, eg from a kettle, is needed to top up the beaker as the temperature falls.
- The yeast suspension is made by stirring 7 g of dried yeast with 450 cm 3 of warm water. If fresh yeast is used it should not have been kept too long. Fresh yeast can be kept in the freezer for up to two months.
- Add 25 g of flour to a beaker and then add 1 g of sugar.

Source: Royal Society of Chemistry
Weigh flour and sugar for a simple bread dough
- Take 30 cm 3 of the yeast suspension in a 50 cm 3 measuring cylinder. Add the yeast suspension to the flour and sugar. Stir with a spatula or glass rod until a smooth paste, which can be poured, has been obtained.
- Pour the paste into a 250 cm 3 measuring cylinder. Take great care not to let the paste touch the sides – this is very important.

Make a paste from the flour, sugar and yeast suspension and pour it into a measuring cylinder
- Note the volume of paste in the cylinder. Place the cylinder in one of the water baths. Record the temperature and note the volume of paste every two minutes for about 30 minutes. A results table is useful here.
- Plot a graph to show how the volume of the dough increases with time. Plotting the results from groups, with the water baths at different temperatures, on the same graph will allow comparison of results.
Teaching notes
It is important that the paste does not touch the sides of the measuring cylinder when the students pour it from the beaker – this is easier said than done. One way of achieving this is to use a large plastic funnel which has had the stem cut off to leave a hole large enough for the paste to flow through the funnel. Alternatively, a suitable plastic drinks bottle could be cut to produce a wide mouthed ‘funnel’.
After 35–45 minutes the protein (gluten) breaks and carbon dioxide gas escapes.
Possible extensions for this activity could be to investigate the effect of substrate concentration (sugar), enzyme concentration and/or pH value on enzyme reactions.
Additional information
This is a resource from the Practical Chemistry project , developed by the Nuffield Foundation and the Royal Society of Chemistry.
Practical Chemistry activities accompany Practical Physics and Practical Biology .
© Nuffield Foundation and the Royal Society of Chemistry
- 11-14 years
- 14-16 years
- Practical experiments
- Biological chemistry
Specification
- 7. Investigate the effect of a number of variables on the rate of chemical reactions including the production of common gases and biochemical reactions.
- 9. Consider chemical reactions in terms of energy, using the terms exothermic, endothermic and activation energy, and use simple energy profile diagrams to illustrate energy changes.
- 2. Develop and use models to describe the nature of matter; demonstrate how they provide a simple way to to account for the conservation of mass, changes of state, physical change, chemical change, mixtures, and their separation.
- Awareness of the contributions of chemistry to society, e.g. provision of pure water, fuels, metals, medicines, detergents, enzymes, dyes, paints, semiconductors, liquid crystals and alternative materials, such as plastics, and synthetic fibres; increasi…
- Enzymes as catalysts produced by living cells (two examples).
Related articles

Why are some plants poisonous to you and your pets?
2024-05-22T08:16:00Z By Kit Chapman
Dig up the toxic secrets of nature’s blooms

Why fermented foods are good for your gut – and your teaching
2024-04-15T05:30:00Z By Emma Davies
From kimchi to kefir, tuck into the complex chemistry of fermentation and its health potential

Sniffing out the science of smells
2024-03-25T04:00:00Z By Hayley Bennett
What makes a bad smell smell bad? Sniff out the chemical culprits behind obnoxious odours
No comments yet
Only registered users can comment on this article., more experiments.

‘Gold’ coins on a microscale | 14–16 years
By Dorothy Warren and Sandrine Bouchelkia
Practical experiment where learners produce ‘gold’ coins by electroplating a copper coin with zinc, includes follow-up worksheet

Practical potions microscale | 11–14 years
By Kirsty Patterson
Observe chemical changes in this microscale experiment with a spooky twist.

Antibacterial properties of the halogens | 14–18 years
By Kristy Turner
Use this practical to investigate how solutions of the halogens inhibit the growth of bacteria and which is most effective
- Contributors
- Email alerts
Site powered by Webvision Cloud
Sciencing_Icons_Science SCIENCE
Sciencing_icons_biology biology, sciencing_icons_cells cells, sciencing_icons_molecular molecular, sciencing_icons_microorganisms microorganisms, sciencing_icons_genetics genetics, sciencing_icons_human body human body, sciencing_icons_ecology ecology, sciencing_icons_chemistry chemistry, sciencing_icons_atomic & molecular structure atomic & molecular structure, sciencing_icons_bonds bonds, sciencing_icons_reactions reactions, sciencing_icons_stoichiometry stoichiometry, sciencing_icons_solutions solutions, sciencing_icons_acids & bases acids & bases, sciencing_icons_thermodynamics thermodynamics, sciencing_icons_organic chemistry organic chemistry, sciencing_icons_physics physics, sciencing_icons_fundamentals-physics fundamentals, sciencing_icons_electronics electronics, sciencing_icons_waves waves, sciencing_icons_energy energy, sciencing_icons_fluid fluid, sciencing_icons_astronomy astronomy, sciencing_icons_geology geology, sciencing_icons_fundamentals-geology fundamentals, sciencing_icons_minerals & rocks minerals & rocks, sciencing_icons_earth scructure earth structure, sciencing_icons_fossils fossils, sciencing_icons_natural disasters natural disasters, sciencing_icons_nature nature, sciencing_icons_ecosystems ecosystems, sciencing_icons_environment environment, sciencing_icons_insects insects, sciencing_icons_plants & mushrooms plants & mushrooms, sciencing_icons_animals animals, sciencing_icons_math math, sciencing_icons_arithmetic arithmetic, sciencing_icons_addition & subtraction addition & subtraction, sciencing_icons_multiplication & division multiplication & division, sciencing_icons_decimals decimals, sciencing_icons_fractions fractions, sciencing_icons_conversions conversions, sciencing_icons_algebra algebra, sciencing_icons_working with units working with units, sciencing_icons_equations & expressions equations & expressions, sciencing_icons_ratios & proportions ratios & proportions, sciencing_icons_inequalities inequalities, sciencing_icons_exponents & logarithms exponents & logarithms, sciencing_icons_factorization factorization, sciencing_icons_functions functions, sciencing_icons_linear equations linear equations, sciencing_icons_graphs graphs, sciencing_icons_quadratics quadratics, sciencing_icons_polynomials polynomials, sciencing_icons_geometry geometry, sciencing_icons_fundamentals-geometry fundamentals, sciencing_icons_cartesian cartesian, sciencing_icons_circles circles, sciencing_icons_solids solids, sciencing_icons_trigonometry trigonometry, sciencing_icons_probability-statistics probability & statistics, sciencing_icons_mean-median-mode mean/median/mode, sciencing_icons_independent-dependent variables independent/dependent variables, sciencing_icons_deviation deviation, sciencing_icons_correlation correlation, sciencing_icons_sampling sampling, sciencing_icons_distributions distributions, sciencing_icons_probability probability, sciencing_icons_calculus calculus, sciencing_icons_differentiation-integration differentiation/integration, sciencing_icons_application application, sciencing_icons_projects projects, sciencing_icons_news news.
- Share Tweet Email Print
- Home ⋅
- Science Fair Project Ideas for Kids, Middle & High School Students ⋅
Biology Experiments on the Fermentation of Yeast

What Are Some Common Uses of Yeast?
Yeast is a fungal microorganism that man has usedsince before he had a written word. Even to this day, it remains a common component of modern beer and bread manufacture. Because it is a simple organism capable of rapid reproduction and even faster metabolism, yeast is an ideal candidate for simple biology science experiments that involve the study of fermentation.
What is Fermentation?
Fermentation is the biological process by which yeast consumes simple sugars and releases alcohol and carbon dioxide. For the most part, fermentation requires a mostly aquatic environment to occur. Different yeasts respond differently to changes in environment, making some better for baking and others for brewing. Bakers use fermentation to add CO2 bubbles to bread dough. During baking, these bubbles make the bread light and fluffy while the alcohol boils away. Brewers take care to preserve the alcohol of fermentation and use the CO2 to help build a frothy head for their potent beverages.
Indirect Life Test Experiments
The first experiment that should come to mind when examining yeast is determining whether or not yeast is a living organism. While it would be easy to rely on foreknowledge about the nature of yeast, more is learned by application of scientific method. If yeast is alive, it should consume food, respire and reproduce. Indirect tests look for clues that these processes are taking place. For such experiments, you should measure the amount of CO2 released by yeast that are digesting sugar water in test tubes with balloons attached. Use Benedict's solution to test for the presence of sugar in the final product.
Salinity Experiments
Fermentation is a delicate process that relies on ideal conditions to occur. Experiments that study how it responds to salinity are of particular interest to science and industry alike. Your project can either take a single type of yeast and vary the amount of salt in the solution to see if there is an ideal salinity, or alternately, use various yeasts to see how they respond to the same level of salt. In the latter experiment, make sure to use yeasts from many industries, since most baker's yeasts fare poorly in saline conditions.
Sugar Experiments
While it's clear that yeast requires sugar for fermentation, there are many different sugars that yeast could use for fuel. You can perform a number of experiments to determine which ones promote the highest level of yeast growth. In one, you can add yeast to various beverages, such as fruit juices and non-carbonated sports drinks to see which environment produces the most CO2. Another can use various sweeteners such as granulated sugars, syrups and nectars (such as agave) placed in weak solutions. You can measure CO2 production with balloons placed over the reacting test tubes, or simply observe the bubbles produced and make a relative comparison.
Related Articles
How to make a vitamin c indicator, what are the independent variables for a moldy bread..., science fair project on the effect of soda on the body, cell respiration experiments, 5 uses of fermentation, girly science fair project ideas, teeth science projects, science project for the effects that beverages have..., how-to science experiments for kids with iodine and..., science projects for cut flowers, simple & easy science fair projects, the effect of temperature on pea respiration, experiments on which mouthwash kills bacteria, chemistry science fair projects, scientific experiment ideas for ap biology, definitions of control, constant, independent and dependent..., cheese mold experiments, how to make a 1% sucrose solution, what happens when there is no oxygen available at the....
- The Science of Cooking: Yeast Air Balloons
About the Author
Andy Klaus started his writing career contributing science and fiction articles to Dickinson High School's newsletters back in 1984. Since then, he has authored novels and written technical books for health-care companies such as VersaSuite. He has covered topics varying from aerospace to zoology and received an associate degree in science from College of the Mainland.
Find Your Next Great Science Fair Project! GO
- Final Sale on Single Boxes: Bony Fish & Fascinating Fungi


Energy Meets Biology for Some Fantastic Results
Our fermentation BioBox helps students understand the concept of energy—specifically, how organisms access energy for biological processes. While most organisms typically use oxygen for energy, some of them don’t. Instead, they access energy through the process of fermentation. In these experiments , students explore fermentation through a practical lens. From their own bodies to fermented foods, they’ll discover just how essential fermentation is in their everyday life.
By the end of this BioBox, your student will address some critical questions about fermentation, and they’ll reach some interesting conclusions:
- What is adenosine triphosphate, or ATP?
- How does temperature affect the fermentation process?
- How do our bodies use fermentation?
- What foods do we make through fermentation, and how are they healthy?

Let the Epic Experiments Begin!
Join the biobox labs newsletter, about biobox labs.
Quick Links
- Science Boxes
- School Orders
- Monthly Kit Videos
- The Open University
- Accessibility hub
- Guest user / Sign out
- Study with The Open University
My OpenLearn Profile
Personalise your OpenLearn profile, save your favourite content and get recognition for your learning
About this free course
Become an ou student, download this course, share this free course.

Start this free course now. Just create an account and sign in. Enrol and complete the course for a free statement of participation or digital badge if available.
3.1.3 Yeast experiment explained

You’ve seen the results of the yeast experiment, but what do these results mean?
Yeasts are microscopic, single-celled organisms, and are a type of fungus that is found all around us, in water, soil, on plants, on animals and in the air. Like all organisms, when yeasts are put in the right type of environment they will thrive; growing and reproducing.
Your experiments were designed to help you identify which environment promotes the most yeast growth. The first three glasses in your experiment contained different temperature environments (cold water, hot water and body temperature water). At very low temperatures the yeast simply does not grow but it is still alive – if the environment were to warm up a bit, it would gradually begin to grow. At very high temperatures the cells within the yeast become damaged beyond repair and even if the temperature of that environment cooled, the yeast would still be unable to grow. At optimum temperatures the yeast thrives.
Your third and fourth glasses both contained environments at optimum temperature (body temperature) for yeast growth, the difference being, the fourth glass was sealed. The variable between these two experiments was the amount of available oxygen. You may have been surprised by your results here, thinking that a living organism in an environment without oxygen cannot survive? However, you should have found that yeast grew pretty well in both experiments.
To understand why yeast was able to thrive in both conditions we need to understand the chemical process occurring in each glass during the experiment. In the three open glasses, oxygen is readily available, and from the moment you added the yeast to the sugar solution it began to chemically convert the sugar in the water and the oxygen in the air into energy, water, and carbon dioxide in a process called aerobic respiration.
Yeast is a slightly unusual organism – it is a ‘facultative anaerobe’. This means that in oxygen-free environments they can still survive. The yeast simply switches from aerobic respiration (requiring oxygen) to anaerobic respiration (not requiring oxygen) and converts its food without oxygen in a process known as fermentation. Due to the absence of oxygen, the waste products of this chemical reaction are different and this fermentation process results in carbon dioxide and ethanol.
Depending on how long you monitored your experiment for and how much space your yeast had to grow you may have noticed that, with time, the experiment sealed with cling film slowed down. This is for two reasons; firstly because less energy is produced by anaerobic respiration than by aerobic respiration and, secondly, because the ethanol produced is actually toxic to the yeast. As the ethanol concentration in the environment increases, the yeast cells begin to get damaged, slowing their growth.
The ethanol produced is a type of alcohol, so it is this process that allows us to use it to make beer and wine. When used in bread making, the yeast begins by respiring aerobically, the carbon dioxide from which makes the bread rise. Eventually the available oxygen is used up, and the yeast switches to anaerobic respiration producing alcohol and carbon dioxide instead. Do not worry though; this alcohol evaporates during the baking process, so you won’t get drunk at lunchtime from eating your sandwiches.
- Science & Math
- Sociology & Philosophy
- Law & Politics
Lab Explained: Production of Yeast Fermentation
- Lab Explained: Production of Yeast…
Introduction
Yeast is commonly known as a baking material for making bread and beer. However, under biological jargon it is a group of eukaryotic, single-celled microorganisms that makes up almost 1% of all fungal species. 1 They are found in soils and on plant surfaces, like flower nectar and fruits, and they reproduce asexually through budding. This is where a small daughter cell grows on the parent cell whose nucleus then duplicates and then separates with the daughter cell. This reproduction can happen at a rate of up to once every 90 minutes. 2 However, some yeast is an exception and reproduces by binary fission, a process in which the DNA duplicates and the cytoplasm splits evenly into two identical daughter cells.
Most importantly, yeast undergoes metabolism without the presence of oxygen, thus respiring anaerobically. The carbon dioxide that is produced is what makes bread rise when using the specific type; Saccharomyces cerevisiae , also known as baker’s yeast.
The breakdown of glucose by yeast:
C6H12O6 → 2C2H5OH + 2CO2
Glucose → ethanol + carbon dioxide
The glucose is broken down by glycolysis. However, there is more to the process than this simple arrow. When respiring anaerobically, yeast performs glycolysis where it converts pyruvate further into ethanol and carbon dioxide. Although the process requires 2 ATP, it produces 4; a net gain of 2 ATP molecules that can be used for energy. Fermentation rate is affected by factors like temperature, saccharide concentration, and type of sugar solution.
Monosaccharides are the monomers 3 of carbohydrates, consisting of glucose, fructose, and galactose. They provide quick, accessible energy that is easily broken down. Disaccharides are made of two monosaccharides, consisting of lactose, maltose, and sucrose. They are held together by a covalent bond 4 through a condensation reaction. 5 Thus, their more complex structures make them harder to break down compared to monosaccharides. These are the sugars and the monomers each sugar is made up of.
| Glucose | Monosaccharide | Monomer (none) | C6H12O6 |
| Fructose | Monosaccharide | Monomer (none) | C6H12O6 |
| Sucrose | Disaccharide | Glucose and fructose | C12H22O11 |
| Lactose | Disaccharide | Glucose and galactose | C12H22O11 |
Investigations
2.1 hypothesis.
Glucose will produce the largest amount of carbon dioxide, followed, by fructose, sucrose, and lactose. Although they all have similar chemical formulas, they differ in structure and
stereochemistry. 6 The monosaccharides will perform better because they require less energy to be broken down and thus create the product of carbon dioxide at a faster and higher rate.
H : The carbon dioxide produced will be the same for each sugar type.
H 1 : The addition of monosaccharides will produce more carbon dioxide than disaccharides.
2.2 Variables
Independent Variable: Type of saccharide
Dependent Variable: Time of each observation (minutes)
Controlled Variables:
- Beaker size: 250ml
- Keeping this consistent would allow the same space for each reaction to take place.
- Amount of yeast: 2.0g
- Type of yeast: Alnatura Backhefe
- Ingredients: Yeast dried from organic farming
- This was important to monitor because different yeast that has different origins could have different reactions.
- Amount of distilled water: 50ml
- Maintaining a consistent amount of ingredients ensured that the chemical reactions would have fair, equal environments.
- Amount of saccharide: 5.0g
Uncontrolled Variables:
- Room temperature: 21°C
- This was monitored using a thermometer. This was important to keep consistent because increased temperatures speed up reactions. However, the lab is quite large, so it was impossible to control this variable.
2.3 Preliminary Experiment
A preliminary experiment was carried out a day before our designated internal assessment time. I thought it was appropriate to prepare for my actual experiment to ensure that all the materials were working, and my procedure demonstrates efficacy. My method was identical to that of my real one, however, I did make one change. Originally, my saccharide to distilled water ratio was 5g:100ml. This was not fitting for my time frame of 30 minutes. Thus, I changed my measurements and made the solution much more concentrated; 5g:50ml. This increased the speed of the reaction so I could take more readings within a smaller span of time, allowing me to also improve my reliability. 7
In addition to adapting my method, I also conducted a control test. I mixed 2g of yeast with 50ml of distilled water and no carbon dioxide was released. Now that I had a method that worked, I could safely move on to my final internal assessment procedure.
3.1 Apparatus
- Gas Syringe – to measure produced carbon dioxide (±0.05ml)
- Mixer – to create and mix the solutions of a saccharide and distilled water
- Stir Rod (or Flea) – magnet used to mix the solutions
- Stands – to hold apparatus in place
- Scale – to measure necessary materials (± 0.05g)
- Stopper – to prevent any carbon dioxide loss throughout the structure
- Clamps – to hold flask and gas syringe in place
- Graduated cylinder – to measure the amount of each ingredient (±0.1ml)
- Flask – to contain the site of the reaction
- Rubber Tube – to connect the glass pipes
- Baking Yeast (Backhafer)
- Glucose, Fructose, Sucrose, Lactose
- Distilled Water – to create solution that is added to yeast
3.2 Methodology
- Pour 2g of yeast into the flask
- Add 50ml distilled water
- Put mixer on 500 rpm
- Record results at both 15 and 30
- The mixture should not release any carbon dioxide, as there is no respiration.
Saccharide Experiment:
- Mix 5g of the saccharide with 50ml distilled water in a beaker until clear
- Make sure the valve is open so the carbon dioxide can flow through to the gas syringe
- Pour the saccharide and distilled water solution into the flask
- Immediately close the flask with the stopper
- Immediately start timer
- Record results at 15 minutes (from gas syringe)
- Stop timer at 30 minutes and record results
- Clean apparatus between uses
- Repeat 4 times per sugar for each sugar
3.3 Justification
All of my measurements for my materials were done with a digital scale where I could control how much of each ingredient I was using down to the nearest milligram. I additionally used two of them, in case one were to malfunction or give a different result. Therefore, I know that I did not have any false readings or amounts or yeast, sugars, or distilled water. Unless, of course, both digital apparatuses malfunctioned.
I repeated my method four times with each sugar to increase reliability and make sure I was getting consistent results. Additionally, when a trial went wrong in any way, I would clean up and re-do it. For example, one time I realized that I had labelled my flask incorrectly and lost track of which sugar I had put in the solution. I properly disposed of it, cleaned the materials, and started over to ensure that I was being accurate, and no leftover waste or excess ingredients would affect the results i.e. each experiment would be independent from one another.
3.4 Risk Assessment
Safety issues: None of the materials I used were harmful or put me at risk in any way.
Ethical issues: Nothing in my internal assessment could be deemed unethical in any way. Environmental issues: The disposal of yeast in a drainage or water system can result in adecrease of oxygen for anything that is further down the pipes. This oxygen shortage can throw off the balance of any ecosystems associated with the drain in question. Thus, I diluted the yeast mixture with water and then disposed of it in the waste container.
Raw and Processed Data
4.1 qualitative observations.
- The saccharide mixture combined with the yeast started to create a layer of froth/bubbles at the top.
- The mixture previously mentioned also left condensation all over the inside of the flask.
- Some sugars were harder to dissolve in the distilled water than others, namely the fructose. This is most likely due to the more complex structure that makes it harder to mingle with the H2O. The more monomers and bonds within a compound, the more difficult it is for any other molecule, in this case water, to interfere and dissolve it.
4.2 Raw Data
| Glucose | 51 | 94 | ||
| 63 | 108 | |||
| 48 | 99 | |||
| 51 | 97 | |||
| Sucrose | 14 | 17 | ||
| 13 | 19 | |||
| 17 | 26 | |||
| 63 | 86 | 8 | ||
| Fructose | 55 | 110 | ||
| 45 | 72 | |||
| 36 | 69 | |||
| 50 | 96 | |||
| Lactose | 18 | 21 | ||
| 15 | 21 | |||
| 10 | 17 | |||
| 15 | 19 |
4.3 Processed Data
From this graph, we can very well see that some sugars simply performed better, specifically glucose and fructose. The disaccharides – fructose and lactose – had a much lower fermentation rate. Thus, my hypothesis is being supported.
| Glucose | 53.25cm | 5.760 | 99.5cm | 5.220 |
| Sucrose | 14.667cm | 1.700 | 20.667cm | 3.859 |
| Fructose | 46.5cm | 7.018 | 86.75cm | 17.020 |
| Lactose | 14.5cm | 2.872 | 19.5cm | 1.658 |
Had I not discarded the anomalies present in my raw data for sucrose, the standard deviations would have been over 5x as large. Because standard deviation is the value describing how much the data differs from the mean, it is very evident that such a large change in the value all due to one anomaly was unnecessary in my final conclusions and analysis of data. It would have negatively impacted the scope of my investigation because it is very obviously due to an error in my method (see weaknesses).
5.1 Conclusion
Looking at table 3 and graph 1, the hierarchy of efficacy in producing carbon dioxide reads as follows; glucose, fructose, sucrose, and lactose. When speaking in terms of standard deviation, sucrose and lactose had the smallest. Table 4 further supports this. Thus, sucrose and lactose were the most consistent and differed the least from their mean. This could be due to the substances being stored correctly or never having been disrupted since their extraction from the lab they were bought from. From table 4, we can further infer that since the F value is greater than the F crit value, the values are not at all equal, rejecting my null hypothesis.
A higher standard deviation, as seen in fructose, could be a result of improper care of the sugars themselves. For example, placing them in warm temperatures or letting them be vulnerable to sunlight could cause them to melt or change in structure and thus alter from molecule to molecule.
Regarding other academic investigations of yeast, my investigation gave results that were expected by other biologists. To quote from the Journal of Undergraduate Biology Laboratory Investigations, “The monosaccharides we used in our experiments (glucose and honey)produced a higher rate of CO2 than the disaccharides (refined sucrose and lactose) did.” This directly aligns with my alternative hypothesis and experiment results.
From my results, it can be concluded that yeast is affected differently depending on the type of saccharide it encounters. Thus, it supports my hypothesis: Glucose will produce the largest
amount of carbon dioxide, followed, by fructose, sucrose, and lactose. As mentioned before, their chemical formulas being almost identical has little to do with it. It is all in the structure. The monosaccharides require less energy to be broken down and thus create the product of carbon dioxide. This is proven by the fact that every cell has the ability to break down glucose, whereas only the liver can break down fructose. 9 Even then, when breaking down fructose, it is first converted into glucose where then glycolysis can take place.
5.2 Improvements
The apparatus I used was not optimal. For example, my mixer did not have a digital display of how fast my rpm was. Thus, I could have been mixing the yeast and sugar solutions at different speeds for each trial. The speed could have affected the rate of the reaction due to how well the molecules were interacting and colliding with each other, and thus affecting the production of carbon dioxide.
In addition, I used quite a large flask compared to the 50ml of solution I had to use. It was made for 250ml, so it is imaginable how much extra space was within the container. This may have decreased the accuracy of the measurements I took from the gas syringe, because there was also gas trapped in the flask itself. Perhaps I could have additionally measured the volume of the container that did not have the solution (the gap between the liquid surface and the gas syringe) and added that to my volumetric values of carbon dioxide to increase my accuracy.
Finally, the yeast packages I used were all from the same store, however it is possible that they were sourced from different farms. Therefore, the structure of the yeast molecules used could have differed due to different methods used while they were farmed. Albeit, this would be a very difficult, arbitrary thing to track, and is a stretch in affecting the results of my assessment.
What my investigation did do extremely well was independence. It is extremely unlikely that and ingredients unintentionally mixed or met due to my rigorous cleaning and replacing of the apparatus. In addition, my method of using the mixer was helpful because it ensured the solutions were extremely even and constant throughout (e.g., no leftover sugar at the bottom).
5.3 Extensions
To extend the current scope of my study, I would be enthusiastic to try and see how different types of yeast would affect my results. In this internal assessment, I only used brewers/baker’s yeast that is simply dried from a farm. However, there are hundreds of other kinds found in a variety of different places. I would measure how these saccharides, and possibly also more, e.g. maltose, affect the fermentation rate of yeasts like torula (used to create paper) and fission yeast (alternative to brewing yeast) or fresh yeast.
Related Posts
- Glucose & Sucrose Fermentation: Carbon Dioxide Production Lab Answers
- Clam Dissection Lab: Explained
- Percent Composition Lab: Explained
- The Energy of Phase Changes Lab Explained
- TLC of ASPIRIN: Lab Explained
Leave a Reply Cancel reply
Your email address will not be published. Required fields are marked *
Save my name, email, and website in this browser for the next time I comment.
Post comment
- Search Menu
Sign in through your institution
- Advance Articles
- High-Impact Collection
- Infographics
- Author Guidelines
- Submission Site
- Open Access
- Self-Archiving Policy
- Why Publish with Us?
- About Journal of Animal Science
- About the American Society of Animal Science
- Editorial Board
- Advertising & Corporate Services
- Journals Career Network
- Journals on Oxford Academic
- Books on Oxford Academic

- < Previous
Effects of a liquid and dry Saccharomyces cerevisiae fermentation product feeding program on ruminal fermentation, total tract digestibility, and plasma metabolome of Holstein steers receiving a grain-based diet
- Article contents
- Figures & tables
- Supplementary Data
Oluwaseun A Odunfa, Anjan Dhungana, Zhengyan Huang, Ilkyu Yoon, Yun Jiang, Effects of a liquid and dry Saccharomyces cerevisiae fermentation product feeding program on ruminal fermentation, total tract digestibility, and plasma metabolome of Holstein steers receiving a grain-based diet, Journal of Animal Science , Volume 102, 2024, skae223, https://doi.org/10.1093/jas/skae223
- Permissions Icon Permissions
The study aimed to determine the effects of a postbiotic feeding program consisting of liquid and dry Saccharomyces cerevisiae fermentation product ( SCFP ) on ruminal fermentation, digestibility, and plasma metabolome of Holstein steers receiving a grain-based diet. Eight Holstein steers (body weight, BW , 467 ± 13.9 kg) equipped with rumen cannulas were used in a crossover design study, with 21 d per period and a 7-d washout period in between periods. Steers were stratified by initial BW and assigned to 1 of 2 treatments. The treatments were 1) Control, basal finishing diet only (CON); 2) SCFP, 1-d feeding of liquid SCFP (infused into the rumen via the cannula at 11 mL/100 kg BW) followed by daily feeding of dry SCFP (12 g/d, top-dressed). Feed and spot fecal samples were collected during days 17 to 20 for determination of digestibility and fecal excretion of N, P, Cu, and Zn. Digestibility was measured using acid-insoluble ash as an internal marker. Blood samples were collected on day 21 before the morning feeding. Rumen fluid samples were collected on days 0, 1, 2, 3, 5, and 21 via rumen cannula. Results were analyzed with the GLIMMIX procedure of SAS 9.4 (SAS, 2023). Treatment did not affect dry matter intake ( P = 0.15) and digestibility ( P ≥ 0.62). The fecal output and absorption of Zn, Cu, P, and N were not affected ( P > 0.22) by treatment. On day 1, the liquid SCFP supplementation tended to reduce ( P = 0.07) ruminal VFA concentration and increased ( P < 0.01) the molar proportion of valerate. Feeding SCFP tended to increase total ruminal VFA on day 5 ( P = 0.08) and significantly increased total VFA on day 21 ( P = 0.05). Ruminal NH 3 –N was reduced ( P = 0.02) on day 21 by supplementing SCFP. Treatment did not affect the production of proinflammatory cytokines, interleukin ( IL )-1β ( P > 0.19), and IL-6 ( P > 0.12) in the whole blood in response to various toll-like receptor stimulants in vitro. Feeding SCFP enriched ( P ≤ 0.05) plasma metabolic pathways, including citric acid cycle, pyrimidine metabolism, glycolysis/gluconeogenesis, retinol metabolism, and inositol phosphate metabolism pathways. In summary, supplementing liquid SCFP with subsequent dry SCFP enhanced ruminal total VFA production and reduced NH 3 –N concentration in the rumen. Furthermore, feeding SCFP enriched several important pathways in lipid, protein, and glucose metabolism, which may improve feed efficiency of energy and protein in Holstein steers.
Lay Summary
Previous research has shown the positive effects of Saccharomyces cerevisiae fermentation product ( SCFP ) on beef cattle performance. Liquid SCFP is a novel form of SCFP and has the potential to prime the rumen environment and improve subsequent ruminal fermentation and performance of Holstein steers receiving a grain-based diet. We investigated the impact of a novel feeding program using liquid and dry SCFP on ruminal fermentation, digestibility, and plasma metabolome of beef steers. Compared to non-supplemented control, feeding SCFP did not affect nutrient digestibility but enhanced ruminal fermentation, as shown by improved total volatile fatty acid production by rumen microbes after 5 d of supplementation. The supplementation of SCFP also enriched several plasma metabolic pathways related to energy and nitrogen metabolism, such as the citric acid cycle, pyrimidine metabolism, and glycolysis/gluconeogenesis pathways.
American Society of Animal Science members
Personal account.
- Sign in with email/username & password
- Get email alerts
- Save searches
- Purchase content
- Activate your purchase/trial code
- Add your ORCID iD
Institutional access
Sign in with a library card.
- Sign in with username/password
- Recommend to your librarian
- Institutional account management
- Get help with access
Access to content on Oxford Academic is often provided through institutional subscriptions and purchases. If you are a member of an institution with an active account, you may be able to access content in one of the following ways:
IP based access
Typically, access is provided across an institutional network to a range of IP addresses. This authentication occurs automatically, and it is not possible to sign out of an IP authenticated account.
Choose this option to get remote access when outside your institution. Shibboleth/Open Athens technology is used to provide single sign-on between your institution’s website and Oxford Academic.
- Click Sign in through your institution.
- Select your institution from the list provided, which will take you to your institution's website to sign in.
- When on the institution site, please use the credentials provided by your institution. Do not use an Oxford Academic personal account.
- Following successful sign in, you will be returned to Oxford Academic.
If your institution is not listed or you cannot sign in to your institution’s website, please contact your librarian or administrator.
Enter your library card number to sign in. If you cannot sign in, please contact your librarian.
Society Members
Society member access to a journal is achieved in one of the following ways:
Sign in through society site
Many societies offer single sign-on between the society website and Oxford Academic. If you see ‘Sign in through society site’ in the sign in pane within a journal:
- Click Sign in through society site.
- When on the society site, please use the credentials provided by that society. Do not use an Oxford Academic personal account.
If you do not have a society account or have forgotten your username or password, please contact your society.
Sign in using a personal account
Some societies use Oxford Academic personal accounts to provide access to their members. See below.
A personal account can be used to get email alerts, save searches, purchase content, and activate subscriptions.
Some societies use Oxford Academic personal accounts to provide access to their members.
Viewing your signed in accounts
Click the account icon in the top right to:
- View your signed in personal account and access account management features.
- View the institutional accounts that are providing access.
Signed in but can't access content
Oxford Academic is home to a wide variety of products. The institutional subscription may not cover the content that you are trying to access. If you believe you should have access to that content, please contact your librarian.
For librarians and administrators, your personal account also provides access to institutional account management. Here you will find options to view and activate subscriptions, manage institutional settings and access options, access usage statistics, and more.
Short-term Access
To purchase short-term access, please sign in to your personal account above.
Don't already have a personal account? Register
| Month: | Total Views: |
|---|---|
| August 2024 | 42 |
| September 2024 | 71 |
Email alerts
Citing articles via.
- Recommend to Your Librarian
- Advertising and Corporate Services
Affiliations
- Online ISSN 1525-3163
- Copyright © 2024 American Society of Animal Science
- About Oxford Academic
- Publish journals with us
- University press partners
- What we publish
- New features
- Open access
- Rights and permissions
- Accessibility
- Advertising
- Media enquiries
- Oxford University Press
- Oxford Languages
- University of Oxford
Oxford University Press is a department of the University of Oxford. It furthers the University's objective of excellence in research, scholarship, and education by publishing worldwide
- Copyright © 2024 Oxford University Press
- Cookie settings
- Cookie policy
- Privacy policy
- Legal notice
This Feature Is Available To Subscribers Only
Sign In or Create an Account
This PDF is available to Subscribers Only
For full access to this pdf, sign in to an existing account, or purchase an annual subscription.
Identification of Yeast Strain YA176 for Bio-Purification of Soy Molasses to Produce Raffinose Family Oligosaccharides and Optimization of Fermentation Conditions
- Original Article
- Published: 28 September 2024
Cite this article

- Zhilei Fu 1 , 2 , 3 ,
- Shuang Cheng 1 ,
- Jinghao Ma 3 ,
- Rana Abdul Basit 3 ,
- Yihua Du 3 ,
- Shubin Tian 4 &
- Guangsen Fan ORCID: orcid.org/0000-0001-5758-130X 1 , 3 , 4
Soybean molasses, which contains high levels of raffinose family oligosaccharides (RFOs) such as stachyose and raffinose, is subjected to a process of bio-purification to remove sucrose while maintaining the RFOs, consequently increasing its value. This study employed morphological observation, physiological and biochemical studies, and molecular biology techniques to identify YA176, a yeast strain renowned for its effective bio-purification of soy molasses. Through single-factor and orthogonal experiments, optimal bio-purification conditions were established. YA176, belonging to Wickerhamomyces anomalus , demonstrated robust growth across a wide range of temperature and pH levels, coupled with remarkable tolerance to glucose, sucrose, and NaCl up to 41.2%, 47.3%, and 10%, respectively. Under these optimized conditions, YA176 efficiently utilized sucrose while preserving 93.3% of raffinose and 78.6% of stachyose, ensuring the retention of functional RFOs. In summary, yeast strain YA176 exhibits exceptional bio-purification abilities, making it an ideal candidate for producing functional RFOs from soy molasses.
This is a preview of subscription content, log in via an institution to check access.
Access this article
Subscribe and save.
- Get 10 units per month
- Download Article/Chapter or eBook
- 1 Unit = 1 Article or 1 Chapter
- Cancel anytime
Price includes VAT (Russian Federation)
Instant access to the full article PDF.
Rent this article via DeepDyve
Institutional subscriptions
Data Availability
All generated or analyzed data as well as the utilized software and materials have been included in the published article. The generated results during the study are available from the corresponding authors upon reasonable request.
Silva, F. B. D., Romao, B. B., Cardoso, V. L., Filho, U. C., & Ribeiro, E. J. (2012). Production of ethanol from enzymatically hydrolyzed soybean molasses. Biochemical Engineering Journal, 69 , 61–68.
Article Google Scholar
Rakita, S., Banjac, V., Djuragic, O., Cheli, F., & Pinotti, L. (2021). Soybean molasses in animal nutrition. Animals, 11 , 514.
Article PubMed PubMed Central Google Scholar
Wang, X. H., Tian, J. J., & Wang, D. (2010). Comprehensive utilization of soybean molasses. Science and Technology of Cereals, Oils and Foods, 18 , 22–24.
CAS Google Scholar
Zhang, L. L., Yang, W. W., & Zhang, Y. Z. (2009). Study on soybean oligosaccharide separated from soy molasses. Science and Technology of Food Industry, 30 , 258–260.
Cheng, C., Zhou, Y. P., Lin, M., Wei, P. L., & Yang, S. T. (2017). Polymalic acid fermentation by Aureobasidium pullulans for malic acid production from soybean hull and soy molasses: Fermentation kinetics and economic analysis. Bioresource Technology, 223 , 166–174.
Article CAS PubMed Google Scholar
Long, C. C., & Gibbons, W. R. (2013). Conversion of soy molasses, soy solubles, and dried soybean carbohydrates into ethanol. International Journal of Agricultural and Biological Engineering, 6 , 62–68.
Rodrigues, M. S., Moreira, F. S., Cardoso, V. L., & de Resende, M. M. (2017). Soy molasses as a fermentation substrate for the production of biosurfactant using Pseudomonas aeruginosa ATCC 10145. Environmental Science and Pollution Research, 24 , 18699–18709.
Sancheti, A., Thompson, E. R., & Ju, L. K. (2023). Factors influencing the enzymatic hydrolysis of soy molasses into fermentation feedstock. Enzyme and Microbial Technology, 170 , 110302.
Kanwal, F., Ren, D. X., Kanwal, W., Ding, M. Y., Su, J. Q., & Shang, X. Y. (2023). The potential role of nondigestible raffinose family oligosaccharides as prebiotics. Glycobiology, 33 , 274–288.
Katrolia, P., Liu, X. L., Li, J. Z., & Kopparapu, N. K. (2019). Enhanced elimination of non-digestible oligosaccharides from soy milk by immobilized α-galactosidase: A comparative analysis. Journal of Food Biochemistry, 43 , 13005.
Zhang, R. J., Zhao, Y., Sun, Y. F., Lu, X. S., & Yang, X. B. (2013). Isolation, characterization, and hepatoprotective effects of the raffinose family oligosaccharides from Rehmannia glutinosa Libosch. Journal of Agricultural and Food Chemistry, 61 , 7786–7793.
He, L. W., Zhang, F. R., Jian, Z. Y., Sun, J. C., Chen, J. M., Liapao, V., & He, Q. (2020). Stachyose modulates gut microbiota and alleviates dextran sulfate sodium-induced acute colitis in mice. Saudi Journal of Gastroenterology, 26 , 153.
Jiang, S. S., Li, Q., Han, S. W., Wang, H. P., Tang, X. L., Wang, T., & Meng, X. R. (2023). Study on the anti-inflammatory effect of stachyose by inhibiting TLR4/NF-κB signaling pathway in vitro and in vivo. Clinical and Experimental Pharmacology and Physiology, 50 , 573–582.
Yan, T., Liu, T. Q., Shi, L., Yan, L. J., Li, Z., Zhang, X. N., Dai, X. S., Sun, X. M., & Yang, X. B. (2023). Integration of microbial metabolomics and microbiomics uncovers a novel mechanism underlying the antidiabetic property of stachyose. Journal of Functional Foods, 102 , 105457.
Article CAS Google Scholar
Guo, Y. N., Song, L. Q., Huang, Y. M., Li, X. P., Xiao, Y. C., Wang, Z. H., & Ren, Z. H. (2023). Latilactobacillu ssakei Furu 2019 and stachyose as probiotics, prebiotics, and synbiotics alleviate constipation in mice. Frontiers in Nutrition, 9 , 1039403.
Fernando, W., Hill, J., Zello, G., Tyler, R., Dahl, W., & Van Kessel, A. (2010). Diets supplemented with chickpea or its main oligosaccharide component raffinose modify faecal microbial composition in healthy adults. Beneficial Microbes., 1 , 197–207.
Xu, Y., He, F., Jin, C., Su, J., & Ding, K. (2024). Stachyose with effect on anti-angiogenic activity from Salvia yunnanensis . Journal of Functional Foods, 112 , 105971.
Zhang, Y. J., Sun, Q., Liu, X. Y., Basit, R. A., Ma, J. H., Fu, Z. L., Cheng, L. J., Fan, G. S., & Teng, C. (2024). Screening, identification, and fermentation condition optimization of a high-yield 3-methylthiopropanol yeast and its aroma-producing characteristics. Foods, 13 , 418.
Article CAS PubMed PubMed Central Google Scholar
Nagata, Y. D., Osono, T., Hasegawa, M., Hobara, S., Hirose, D., Tanabe, Y., Kudoh, S., & Uchida, M. (2023). Application of the Biolog EcoPlate™ technique for assessing the microbial metabolic diversity in moss profiles of continental antarctica. Polar Science, 35 , 100924.
Zhao, H., Duan, S. L., He, C. F., Wang, L., Song, J., Wang, X., & Chen, Z. R. (2011). Purification of oligosaccharides through fermentation technology with screening of strains. Science and Technology Review, 29 , 24–28.
Liu, Y. L., Tian, Y., & Bao, D. Q. (2010). Preparation of functional soybean oligosaccharides from soybean molasses by fermentation. Journal of Henan University of Technology (Natural Science Edition), 31 , 1–5.
Google Scholar
Yang, R., Zhong, X. F., Tang, Y. B., Ma, J. H., Tian, S. B., Du, Y. H., & Fan, G. S. (2024). Screening of microbial strains for the production of functional soybean oligosaccharides from soybean molasses. China Brewing, 43 , 88–95.
Buchana, R. E., & Gibbons, N. E. (1984). Bergey’s manual of determinative bacteriology (8th ed., pp. 382–533). Science Press.
Dong, X. Z., & Cai, M. Y. (2001). Ommon Bacteria manual system identification (pp. 348–392). Science Press.
Fan, G. S., Sun, B. G., Xu, D., Teng, C., Fu, Z. L., Du, Y. H., & Li, X. T. (2018). Isolation and identification of high-yield ethyl acetate-producing yeast from Gujinggong Daqu and its fermentation characteristics. Journal of the American Society of Brewing Chemists, 76 , 117–124.
Ma, J. H., Cheng, L. J., Zhang, Y. J., Liu, Y. C., Sun, Q., Zhang, J., Liu, X. Y., & Fan, G. S. (2022). Screening of yeasts isolated from Baijiu environments for producing 3-methylthio-1-propanol and optimizing production conditions. Foods, 11 , 3616.
Li, S., Wang, X., Tu, J., Qiao, B., & Li, J. (2016). Nitrogen removal in an ecological ditch based on an orthogonal test. Water, Air, & Soil Pollution, 227 , 1–9.
Zhou, R. L., Ren, Z. Q., Ye, J., Fan, Y. W., Liu, X. R., Yang, J. Y., Deng, Z. Y., & Li, J. (2019). Fermented soybean dregs by Neurospora crassa : A traditional prebiotic food. Applied Biochemistry and Biotechnology, 189 , 608–625.
Francesca, N., Carvalho, C., Almeida, P. M., Sannino, C., Settanni, L., Sampaio, J. P., & Moschetti, G. (2013). Wickerhamomyces sylviae f.a., sp. nov., an ascomycetous yeast species isolated from migratory birds. International Journal of Systematic and Evolutionary Microbiology, 63 , 4824–4830.
Padilla, B., Gil, J. V., & Manzanares, P. (2018). Challenges of the non-conventional yeast Wickerhamomyces anomalus in winemaking. Fermentation, 4 (3), 68.
Sabel, A., Martens, S., Petri, A., König, H., & Claus, H. (2014). Wickerhamomyces anomalus AS1: A new strain with potential to improve wine aroma. Annals of Microbiology, 64 , 483–491.
Fan, G. S., Liu, P. X., Chang, X., Yin, H., Cheng, L. J., Teng, C., Gong, Y., & Li, X. T. (2021). Isolation and identification of a high-yield ethyl caproate-producing yeast from Daqu and optimization of its fermentation. Frontiers in Microbiology, 12 , 663744.
Fan, G. S., Cheng, L. J., Fu, Z. L., Sun, B. G., Teng, C., Jiang, X. Y., & Li, X. T. (2020). Screening of yeasts isolated from Baijiu environments for 2-phenylethanol production and optimization of production conditions. 3 Biotech, 10 , 275.
Fan, G. S., Liu, P. X., Wu, Q. H., Fu, Z. L., Cheng, L. J., Zhu, Y. T., Zhu, Y. P., Yang, R., & Li, X. T. (2019). Optimization of cultural conditions for ethyl alcohol production by Saccharomyces cerevisiae YF1914 in aerobic conditions. Science and Technology of Food Industry, 40 , 52–58.
Zhang, J. G. (2019). Master thesis. Biological purification and transformation of functional components in soybean molasses. Tianjin University of Science and Technology .
Liu, F., Li, X. X., Ge, H. R., Qi, X. F., & Yu, D. Y. (2016). The preparation of functional oligosaccharide in the process of fermentation from soybean molasses. The Food Industry, 37 , 93–98.
Fang, W. H. (2004). Master thesis. Isolation of the soybean molasses and the microbiological purification of the oligosaccharide composition. Jiangnan University .
Cui, X. Q., Liu, C., Dong, Y. M., He, C. F., & Wang, C. T. (2009). Isolation and purification of oligosaccharides from soybean molasses through fermentation. Food Science, 30 , 343–346.
Download references
This research was supported by the Open Research Fund Program of Henan Key Laboratory of Industrial Microbial Resources and Fermentation Technology (HIMFT20190205), Doctoral Research Initiation Fund, Hebei Normal University for Nationalities (DR2022004), and Beijing Natural Science Foundation (6222003 and 6164029).
Author information
Authors and affiliations.
Henan Key Laboratory of Industrial Microbial Resources and Fermentation Technology, Nanyang Institute of Technology, Nanyang, 473004, Henan, China
Zhilei Fu, Shuang Cheng & Guangsen Fan
School of Biology and Food Science, Hebei MinZu Normal University, Chengde, 067000, China
Key Laboratory of Geriatric Nutrition and Health (Beijing Technology and Business University), Ministry of Education, No. 11, Fucheng Road, Haidian District, Beijing, 100048, China
Zhilei Fu, Jinghao Ma, Rana Abdul Basit, Yihua Du & Guangsen Fan
Sweet Code Nutrition and Health Institute, Zibo, 256306, China
Shubin Tian & Guangsen Fan
You can also search for this author in PubMed Google Scholar
Contributions
Zhilei Fu and Yihua Du have performed the experimental analysis study. Jinghao Ma and Shubin Tian have carried out the analysis and interpretation of the results. Zhilei Fu wrote the manuscript. Shuang Cheng and Guangsen Fan have designed the study concept and interpreted the data. Rana Abdul Basit read and revised the manuscript and approved the final version. All authors read and approved the final manuscript.
Corresponding author
Correspondence to Guangsen Fan .
Ethics declarations
Ethics approval and consent to participate.
This article does not contain any studies with human participants or animals performed by any of the authors.
Consent for Publication
Not applicable.
Conflict of Interest
The authors declare no competing interests.
Additional information
Publisher's note.
Springer Nature remains neutral with regard to jurisdictional claims in published maps and institutional affiliations.
Supplementary Information
Below is the link to the electronic supplementary material.
Supplementary file1 (DOCX 442 KB)
Rights and permissions.
Springer Nature or its licensor (e.g. a society or other partner) holds exclusive rights to this article under a publishing agreement with the author(s) or other rightsholder(s); author self-archiving of the accepted manuscript version of this article is solely governed by the terms of such publishing agreement and applicable law.
Reprints and permissions
About this article
Fu, Z., Cheng, S., Ma, J. et al. Identification of Yeast Strain YA176 for Bio-Purification of Soy Molasses to Produce Raffinose Family Oligosaccharides and Optimization of Fermentation Conditions. Appl Biochem Biotechnol (2024). https://doi.org/10.1007/s12010-024-05065-4
Download citation
Accepted : 19 September 2024
Published : 28 September 2024
DOI : https://doi.org/10.1007/s12010-024-05065-4
Share this article
Anyone you share the following link with will be able to read this content:
Sorry, a shareable link is not currently available for this article.
Provided by the Springer Nature SharedIt content-sharing initiative
- Soy Molasses
- Raffinose Family Oligosaccharides
- Bio-purification
- Wickerhamomyces Anomalus
- Find a journal
- Publish with us
- Track your research
Information
- Author Services
Initiatives
You are accessing a machine-readable page. In order to be human-readable, please install an RSS reader.
All articles published by MDPI are made immediately available worldwide under an open access license. No special permission is required to reuse all or part of the article published by MDPI, including figures and tables. For articles published under an open access Creative Common CC BY license, any part of the article may be reused without permission provided that the original article is clearly cited. For more information, please refer to https://www.mdpi.com/openaccess .
Feature papers represent the most advanced research with significant potential for high impact in the field. A Feature Paper should be a substantial original Article that involves several techniques or approaches, provides an outlook for future research directions and describes possible research applications.
Feature papers are submitted upon individual invitation or recommendation by the scientific editors and must receive positive feedback from the reviewers.
Editor’s Choice articles are based on recommendations by the scientific editors of MDPI journals from around the world. Editors select a small number of articles recently published in the journal that they believe will be particularly interesting to readers, or important in the respective research area. The aim is to provide a snapshot of some of the most exciting work published in the various research areas of the journal.
Original Submission Date Received: .
- Active Journals
- Find a Journal
- Journal Proposal
- Proceedings Series
- For Authors
- For Reviewers
- For Editors
- For Librarians
- For Publishers
- For Societies
- For Conference Organizers
- Open Access Policy
- Institutional Open Access Program
- Special Issues Guidelines
- Editorial Process
- Research and Publication Ethics
- Article Processing Charges
- Testimonials
- Preprints.org
- SciProfiles
- Encyclopedia

Article Menu

- Subscribe SciFeed
- Recommended Articles
- Google Scholar
- on Google Scholar
- Table of Contents
Find support for a specific problem in the support section of our website.
Please let us know what you think of our products and services.
Visit our dedicated information section to learn more about MDPI.
JSmol Viewer
Sustainable exploitation of wine lees as yeast extract supplement for application in food industry and its effect on the growth and fermentative ability of lactiplantibacillus plantarum and saccharomyces cerevisiae.

1. Introduction
2. materials and methods, 2.1. materials, 2.2. production of wine lees yeast extract powder, 2.3. inoculum preparation, 2.4. test culture media, growth monitoring and cell enumeration, 2.5. data analysis, 2.6. evaluation of fermentative ability, 2.7. determination of ph, reducing sugars and ethanol content in fermentation media, 2.8. statistical analysis, 3. results and discussion, 3.1. growth kinetics of lactiplantibacillus plantarum 2035, 3.2. growth kinetics of saccharomyces cerevisiae ncyc187, 3.3. fermentative ability, 4. conclusions, supplementary materials, author contributions, institutional review board statement, informed consent statement, data availability statement, conflicts of interest.
- OIV World Statistics. Available online: https://www.oiv.int/what-we-do/global-report?oiv (accessed on 16 January 2024).
- Santos, V.; Ramos, P.; Sousa, B.; Valeri, M. Towards a framework for the global wine tourism system. J. Organ. Chang. Manag. 2022 , 35 , 348–360. [ Google Scholar ] [ CrossRef ]
- Jara-Palacios, M.J. Wine lees as a source of antioxidant compounds. Antioxidants 2019 , 8 , 45. [ Google Scholar ] [ CrossRef ] [ PubMed ]
- Pérez-Bibbins, B.; Torrado-Agrasar, A.; Salgado, J.M.; de Souza Oliveira, R.P.; Domínguez, J.M. Potential of lees from wine, beer and cider manufacturing as a source of economic nutrients: An overview. Waste Manag. 2015 , 40 , 72–81. [ Google Scholar ] [ CrossRef ]
- Dimou, C.; Vlysidis, A.; Kopsahelis, N.; Papanikolaou, S.; Koutinas, A.A.; Kookos, I.K. Techno-economic evaluation of wine lees refining for the production of value-added products. Biochem. Eng. J. 2016 , 116 , 157–165. [ Google Scholar ] [ CrossRef ]
- Oliveira, M.; Duarte, E. Integrated approach to winery waste: Waste generation and data consolidation. Front. Environ. Sci. Eng. 2016 , 10 , 168–176. [ Google Scholar ] [ CrossRef ]
- Kokkinomagoulos, E.; Kandylis, P. Grape pomace, an undervalued by-product: Industrial reutilization within a circular economy vision. Rev. Environ. Sci. Bio/Technol. 2023 , 22 , 739–773. [ Google Scholar ] [ CrossRef ]
- Rodríguez-Salgado, I.; Paradelo-Pérez, M.; Pérez-Rodríguez, P.; Cutillas-Barreiro, L.; Fernández-Calviño, D.; Nóvoa-Muñoz, J.C.; Arias-Estévez, M. Cyprodinil retention on mixtures of soil and solid wastes from wineries. Effects of waste dose and ageing. Environ. Sci. Pollut. Res. 2014 , 21 , 9785–9795. [ Google Scholar ] [ CrossRef ]
- Rugani, B.; Vázquez-Rowe, I.; Benedetto, G.; Benetto, E. A comprehensive review of carbon footprint analysis as an extended environmental indicator in the wine sector. J. Clean. Prod. 2013 , 54 , 61–77. [ Google Scholar ] [ CrossRef ]
- Blanco-Huerta, C.; Rodríguez-Nogales, J.M.; Vila-Crespo, J.; Ruipérez, V.; Fernández-Fernández, E. Impact of high hydrostatic pressure and ultrasounds technologies in the autolytic process of Saccharomyces cerevisiae in a model wine system. Food Biosci. 2024 , 57 , 103614. [ Google Scholar ] [ CrossRef ]
- Devesa-Rey, R.; Vecino, X.; Varela-Alende, J.L.; Barral, M.T.; Cruz, J.M.; Moldes, A.B. Valorization of winery waste vs. the costs of not recycling. Waste Manag. 2011 , 31 , 2327–2335. [ Google Scholar ] [ CrossRef ]
- Bustos, G.; Moldes, A.B.; Cruz, J.M.; Domínguez, J.M. Formulation of low-cost fermentative media for lactic acid production with Lactobacillus rhamnosus using vinification lees as nutrients. J. Agric Food Chem. 2004 , 52 , 801–808. [ Google Scholar ] [ CrossRef ] [ PubMed ]
- Giamouri, E.; Mavrommatis, A.; Simitzis, P.E.; Mitsiopoulou, C.; Haroutounian, S.A.; Koutinas, A.; Pappas, A.C.; Tsiplakou, E. Redefining the Use of Vinification Waste By-Products in Broiler Diets. Sustainability 2022 , 14 , 15714. [ Google Scholar ] [ CrossRef ]
- Kokkinomagoulos, E.; Kandylis, P. Sustainable exploitation of by-products of vitivinicultural origin in winemaking. Proceedings 2020 , 67 , 5. [ Google Scholar ] [ CrossRef ]
- Scarponi, P.; Caminiti, V.; Bravi, M.; Izzo, F.C.; Cavinato, C. Coupling anaerobic co-digestion of winery waste and waste activated sludge with a microalgae process: Optimization of a semi-continuous system. Waste Manag. 2024 , 174 , 300–309. [ Google Scholar ] [ CrossRef ] [ PubMed ]
- De Iseppi, A.; Lomolino, G.; Marangon, M.; Curioni, A. Current and future strategies for wine yeast lees valorization. Food Res. Int. 2020 , 137 , 109352. [ Google Scholar ] [ CrossRef ] [ PubMed ]
- Schlabitz, C.; Lehn, D.N.; de Souza, C.F.V. A review of Saccharomyces cerevisiae and the applications of its byproducts in dairy cattle feed: Trends in the use of residual brewer’s yeast. J. Clean. Prod. 2022 , 332 , 130059. [ Google Scholar ] [ CrossRef ]
- Pérez-Bibbins, B.; Torrado-Agrasar, A.; Pérez-Rodríguez, N.; Aguilar-Uscanga, M.G.; Domínguez, J.M. Evaluation of the liquid, solid and total fractions of beer, cider and wine lees as economic nutrient for xylitol production. J. Chem. Technol. Biotechnol. 2015 , 90 , 1027–1039. [ Google Scholar ] [ CrossRef ]
- IndustryARC, Yeast Extracts Market–Forecast (2025–2032). Available online: https://www.industryarc.com/Report/18940/yeast-extracts-market (accessed on 17 January 2024).
- Global Market Insights, Yeast Extract Market Size By Technology (Autolyzed Yeast, Hydrolyzed Yeast), By Source (Bakers Yeast, Brewers Yeast, Torula Yeast), By Application (Food & Beverages, Animal Feed, Pharmaceuticals), By Form (Powder, Paste) & Forecast, 2023–2032. Available online: https://www.gminsights.com/industry-analysis/yeast-extract-market (accessed on 16 January 2024).
- Salgado, J.M.; Rodriguez, N.; Cortes, S.; Domínguez, J.M. Development of cost-effective media to increase the economic potential for larger-scale bioproduction of natural food additives by Lactobacillus rhamnosus , Debaryomyces hansenii , and Aspergillus niger . J. Agric. Food Chem. 2009 , 57 , 10414–10428. [ Google Scholar ] [ CrossRef ]
- Dimou, C.; Kopsahelis, N.; Papadaki, A.; Papanikolaou, S.; Kookos, I.K.; Mandala, I.; Koutinas, A.A. Wine lees valorization: Biorefinery development including production of a generic fermentation feedstock employed for poly (3-hydroxybutyrate) synthesis. Food Res. Int. 2015 , 73 , 81–87. [ Google Scholar ] [ CrossRef ]
- Rivas, B.; Torrado, A.; Moldes, A.B.; Domínguez, J.M. Tartaric acid recovery from distilled lees and use of the residual solid as an economic nutrient for Lactobacillus . J. Agric. Food Chem. 2006 , 54 , 7904–7911. [ Google Scholar ] [ CrossRef ]
- Balmaseda, A.; Miot-Sertier, C.; Lytra, G.; Poulain, B.; Reguant, C.; Lucas, P.; Nioi, C. Application of white wine lees for promoting lactic acid bacteria growth and malolactic fermentation in wine. Int. J. Food Microbiol. 2024 , 413 , 110583. [ Google Scholar ] [ CrossRef ] [ PubMed ]
- Baranyi, J.; Roberts, T.A. A dynamic approach to predicting bacterial growth in food. Int. J. Food Microbiol. 1994 , 23 , 277–294. [ Google Scholar ] [ CrossRef ] [ PubMed ]
- Kallis, M.; Sideris, K.; Kopsahelis, N.; Bosnea, L.; Kourkoutas, Y.; Terpou, A.; Kanellaki, M. Pistacia terebinthus resin as yeast immobilization support for alcoholic fermentation. Foods 2019 , 8 , 127. [ Google Scholar ] [ CrossRef ] [ PubMed ]
- Wang, X.J.; Li, Y.K.; Song, H.C.; Tao, Y.S.; Russo, N. Phenolic matrix effect on aroma formation of terpenes during simulated wine fermentation–Part I: Phenolic acids. Food Chem. 2021 , 341 , 128288. [ Google Scholar ] [ CrossRef ] [ PubMed ]
- Miller, G.L. Use of dinitrosalicylic acid reagent for determination of reducing sugar. Anal. Chem. 1959 , 31 , 426–428. [ Google Scholar ] [ CrossRef ]
- Champagne, C.P.; Gaudreau, H.; Conway, J. Effect of the production or use of mixtures of bakers’ or brewers’ yeast extracts on their ability to promote growth of lactobacilli and pediococci. Electron. J. Biotechnol. 2003 , 6 , 185–197. [ Google Scholar ] [ CrossRef ]
- Horn, S.J.; Aspmo, S.I.; Eijsink, V.G.H. Growth of Lactobacillus plantarum in media containing hydrolysates of fish viscera. J. Appl. Microbiol. 2005 , 99 , 1082–1089. [ Google Scholar ] [ CrossRef ]
- Silva, A.P.R.D.; Longhi, D.A.; Dalcanton, F.; Aragão, G.M.F.D. Modelling the growth of lactic acid bacteria at different temperatures. Braz. Arch. Biol. Technol. 2018 , 61 , e18160159. [ Google Scholar ] [ CrossRef ]
- Di Cagno, R.; De Angelis, M.; Upadhyay, V.K.; McSweeney, P.L.; Minervini, F.; Gallo, G.; Gobbetti, M. Effect of proteinases of starter bacteria on the growth and proteolytic activity of Lactobacillus plantarum DPC2741. Int. Dairy J. 2003 , 13 , 145–157. [ Google Scholar ] [ CrossRef ]
- Ardré, M.; Doulcier, G.; Brenner, N.; Rainey, P.B. Interaction among bacterial cells triggers exit from lag phase. bioRxiv 2022 . [ Google Scholar ] [ CrossRef ]
- García-Ríos, E.; Gutiérrez, A.; Salvadó, Z.; Arroyo-López, F.N.; Guillamon, J.M. The fitness advantage of commercial wine yeasts in relation to the nitrogen concentration, temperature, and ethanol content under microvinification conditions. Appl. Environ. Microbiol. 2014 , 80 , 704–713. [ Google Scholar ] [ CrossRef ] [ PubMed ]
- Arroyo-López, F.N.; Orlić, S.; Querol, A.; Barrio, E. Effects of temperature, pH and sugar concentration on the growth parameters of Saccharomyces cerevisiae , S. kudriavzevii and their interspecific hybrid. Int. J. Food Microbiol. 2009 , 131 , 120–127. [ Google Scholar ] [ CrossRef ] [ PubMed ]
- Onetto, C.; McCarthy, J.; Solomon, M.; Borneman, A.R.; Schmidt, S.A. Enhancing fermentation performance through the reutilisation of wine yeast lees. OENO One 2024 , 58 . [ Google Scholar ] [ CrossRef ]
- Balmaseda, A.; Rozès, N.; Leal, M.Á.; Bordons, A.; Reguant, C. Impact of changes in wine composition produced by non- Saccharomyces on malolactic fermentation. Int. J. Food Microbiol. 2021 , 337 , 108954. [ Google Scholar ] [ CrossRef ]
- Onetto, C.A.; Bordeu, E. Pre-alcoholic fermentation acidification of red grape must using Lactobacillus plantarum . Antonie Leeuwenhoek 2015 , 108 , 1469–1475. [ Google Scholar ] [ CrossRef ]
Click here to enlarge figure
| Culture Media Base | Type of Yeast Extract | Concentration (g L ) | Coding |
|---|---|---|---|
| Lactiplantibacillus plantarum 2035 | |||
| MRS broth | CYE | 5 | C |
| WLYE | 5 | WL | |
| CYE + WLYE | 2.5 + 2.5 | C + WL | |
| Saccharomyces cerevisiae NCYC187 | |||
| Yeast Carbon Base | CYE | 0.5 | C0.5 |
| CYE | 1 | C1 | |
| CYE | 2 | C2 | |
| CYE | 5 | C5 | |
| CYE | 10 | C10 | |
| WLYE | 1 | WL1 | |
| WLYE | 2 | WL2 | |
| WLYE | 5 | WL5 | |
| WLYE | 10 | WL10 | |
| CYE + WLYE | 0.5 + 5 | C0.5 + WL5 | |
| The statements, opinions and data contained in all publications are solely those of the individual author(s) and contributor(s) and not of MDPI and/or the editor(s). MDPI and/or the editor(s) disclaim responsibility for any injury to people or property resulting from any ideas, methods, instructions or products referred to in the content. |
Share and Cite
Kokkinomagoulos, E.; Kandylis, P. Sustainable Exploitation of Wine Lees as Yeast Extract Supplement for Application in Food Industry and Its Effect on the Growth and Fermentative Ability of Lactiplantibacillus plantarum and Saccharomyces cerevisiae . Sustainability 2024 , 16 , 8449. https://doi.org/10.3390/su16198449
Kokkinomagoulos E, Kandylis P. Sustainable Exploitation of Wine Lees as Yeast Extract Supplement for Application in Food Industry and Its Effect on the Growth and Fermentative Ability of Lactiplantibacillus plantarum and Saccharomyces cerevisiae . Sustainability . 2024; 16(19):8449. https://doi.org/10.3390/su16198449
Kokkinomagoulos, Evangelos, and Panagiotis Kandylis. 2024. "Sustainable Exploitation of Wine Lees as Yeast Extract Supplement for Application in Food Industry and Its Effect on the Growth and Fermentative Ability of Lactiplantibacillus plantarum and Saccharomyces cerevisiae " Sustainability 16, no. 19: 8449. https://doi.org/10.3390/su16198449
Article Metrics
Article access statistics, supplementary material.
ZIP-Document (ZIP, 160 KiB)
Further Information
Mdpi initiatives, follow mdpi.

Subscribe to receive issue release notifications and newsletters from MDPI journals

IMAGES
VIDEO
COMMENTS
Introduction. Enzyme catalysis 1 is an important topic which is often neglected in introductory chemistry courses. In this paper, we present a simple experiment involving the yeast-catalyzed fermentation of sugars. The experiment is easy to carry out, does not require expensive equipment and is suitable for introductory chemistry courses.
Swirl the flask to dissolve the glucose. Add 1 g of yeast to the solution and loosely plug the top of the flask with cotton wool. Wait while fermentation takes place. The time it takes will depend on the temperature, how well you mixed the reactants and the yeast's freshness. Add 5 cm 3 of limewater to the boiling tube.
Yeast Fermentation Experiment Investigate how different types of sugar (white, brown, and honey) affect the rate of yeast fermentation by measuring the amount of carbon dioxide (CO₂) produced. Example Hypothesis: If yeast is added to different types of sugar, then the type of sugar will affect the amount of carbon dioxide produced, with white ...
Introduction. Yeast can metabolize sugar in two ways, aerobically, with the aid of oxygen, or anaerobically, without oxygen. When yeast metabolizes a sugar under anaerobic conditions, ethanol (CH 3 CH 2 OH) and carbon dioxide (CO 2) gas are produced. An equation for the fermentation of the simple sugar glucose (C 6 H 12 O 6) is:
The yeast in glass 1 was activated by adding warm water and sugar. The foaming results from the yeast eating the sucrose. Did glass 1 smell different? Typically, the sugar fermentation process gives off heat and/or gas as a waste product. In this experiment glass 1 gave off carbon dioxide as its waste.
Step 6: Fermentation; Result: Matching game; Test the gas; Red Litmus paper test; Blue litmus paper test; Result Indication; Explanation - Flask 1; Explanation - Flask 2; Explanation - Flask 3; Explanation - Flask 4; Explanation - Flask 5; Principle Used in Experiment
Welcome to science at home in this experiment we are exploring the fermentation between yeast and sugar. Yeast uses sugar as energy and releases carbon dioxi...
with. It also depends on the freshness of the yeast. Dried yeast does work. If fermentation is not rapid because of the yeast used, then carry the whole experiment over to the next lesson. For an alternative practical arrangement to part 1, use a bung and delivery tube to bubble the carbon dioxide through limewater. Or watch the Identifying ions
Yeast are unicellular fungi that can perform aerobic respiration when oxygen is plentiful, but they can also obtain energy by the anaerobic process of fermentation when it is not. When yeast cells carry out fermentation, they convert sugar molecules into ethyl alcohol (C2H5OH) and CO2. Ethanol is another name for ethyl alcohol.
Introduction. Yeast can metabolize sugar in two ways, aerobically, with the aid of oxygen, or anaerobically, without oxygen. When yeast metabolizes a sugar under anaerobic conditions, ethanol (CH 3 CH 2 OH) and carbon dioxide (CO 2) gas are produced. An equation for the fermentation of the simple sugar glucose (C 6 H 12 O 6) is:
Add 2 teaspoon of yeast to glass/plastic container. Pour the boiled glucose solution into the same container. Use a spoon/straw to gently mix. Carefully pour half tablespoon of vegetable oil into the container so that it rests on top of the yeast-glucose mixture to keep oxygen from entering the system.
The formula for the yeast fermentation reaction is: C 6H 12O 6 = 2CH 3 CH 2 OH + 2CO 2 + energy glucose = ethyl + carbon alcohol dioxide For the yeast cell, this chemical reaction is necessary to produce the energy for life. The alcohol and the carbon dioxide are waste products produced by the yeast. It is
In this lab, you will try to determine whether yeast are capable of metabolizing a variety of sugars. Although the aerobic fermentation of sugars is much more efficient, in this experiment we will have yeast ferment the sugars anaerobically. When the yeast respire aerobically, oxygen gas is consumed at the same rate that CO 2 is produced ...
In this experiment we are exploring the fermentation between yeast and sugar. Yeast uses sugar as energy and releases carbon dioxide and ethanol as waste. Yeast and fermentation have been used for thousands of years when making bread. At the end of this episode you will be able to demonstrate fermentation, explain why yeast and fermentation make a balloon grow and explain the chemical reaction ...
The experiment provided a clear insight into the basic chemical reactions needed to produce alcohol. ... This discovery paved the way to understand the role of yeast in fermentation.
During the experiment, 500ml water bottles were used. Then 50ml of lukewarm water was added to each bottle, after that, ½ teaspoon of sugar was added to the 1 st bottle then ¼ teaspoon of sugar was added to the 2 nd bottle. Finally, ½ teaspoon of rapid-rise yeast was added to both bottles, then the balloons were placed on each tube and ...
Take 30 cm 3 of the yeast suspension in a 50 cm 3 measuring cylinder. Add the yeast suspension to the flour and sugar. Stir with a spatula or glass rod until a smooth paste, which can be poured, has been obtained. Pour the paste into a 250 cm 3 measuring cylinder. Take great care not to let the paste touch the sides - this is very important.
Biology Experiments on the Fermentation of Yeast. Yeast is a fungal microorganism that man has usedsince before he had a written word. Even to this day, it remains a common component of modern beer and bread manufacture. Because it is a simple organism capable of rapid reproduction and even faster metabolism, yeast is an ideal candidate for ...
Our fermentation BioBox helps students understand the concept of energy—specifically, how organisms access energy for biological processes. While most organisms typically use oxygen for energy, some of them don't. Instead, they access energy through the process of fermentation. In these experiments, students explore fermentation through a ...
Fermentation using lactic acid is frequently used to make foods like yogurt, pickles, and sauerkraut. Alcoholic fermentation is one of the oldest and most significant fermentation processes used in the biotechnology industry. Alcoholic fermentation occurs in the yeast's cytoplasm without oxygen (Sablayrolles, 2009; Stanbury et al., 2013).
Yeasts must get their food from their surrounding environment to grow and reproduce, or make more yeast. What do they eat? Yeasts feed on sugars and starches, which are in bread dough.They turn their food into energy and release carbon dioxide (CO 2) gas as a result. This process is known as fermentation.The CO 2 gas made during fermentation is what makes a slice of bread so soft and spongy.
The yeast simply switches from aerobic respiration (requiring oxygen) to anaerobic respiration (not requiring oxygen) and converts its food without oxygen in a process known as fermentation. Due to the absence of oxygen, the waste products of this chemical reaction are different and this fermentation process results in carbon dioxide and ethanol.
Mix 5g of the saccharide with 50ml distilled water in a beaker until clear. Pour 2g of yeast into the flask. Make sure the valve is open so the carbon dioxide can flow through to the gas syringe. Pour the saccharide and distilled water solution into the flask. Immediately close the flask with the stopper.
Introduction. Maintaining a healthy and stable rumen environment is crucial for efficient nutrient utilization, production, and gut health of ruminants (Plaizier et al., 2012).Saccharomyces cerevisiae fermentation products (SCFPs) are produced through the anaerobic fermentation of yeast and contain a wide range of beneficial substances, including antioxidants, vitamins, oligosaccharides ...
Single-Factor Experiment Optimization of Yeast Strain YA176 for Bio-Purification of Soy Molasses and Production of RFOs ... This dilution factor was the same as that required for yeast fermentation of soy molasses by yeast strain no. 7 but higher than that needed for maltose yeast [35, 38]. This difference may be attributed to variations in the ...
Wine lees, the residue left behind after racking or bottling of wine, are predominantly composed of dead yeast cells, ethanol, phenolic compounds, and tartrates. Yeast extract (i.e., commercial yeast extract), a highly nutritious powder derived from commercially cultivated yeast biomass, is commonly used in nutrient media as a nitrogen source. In the context of by-product valorization, wine ...